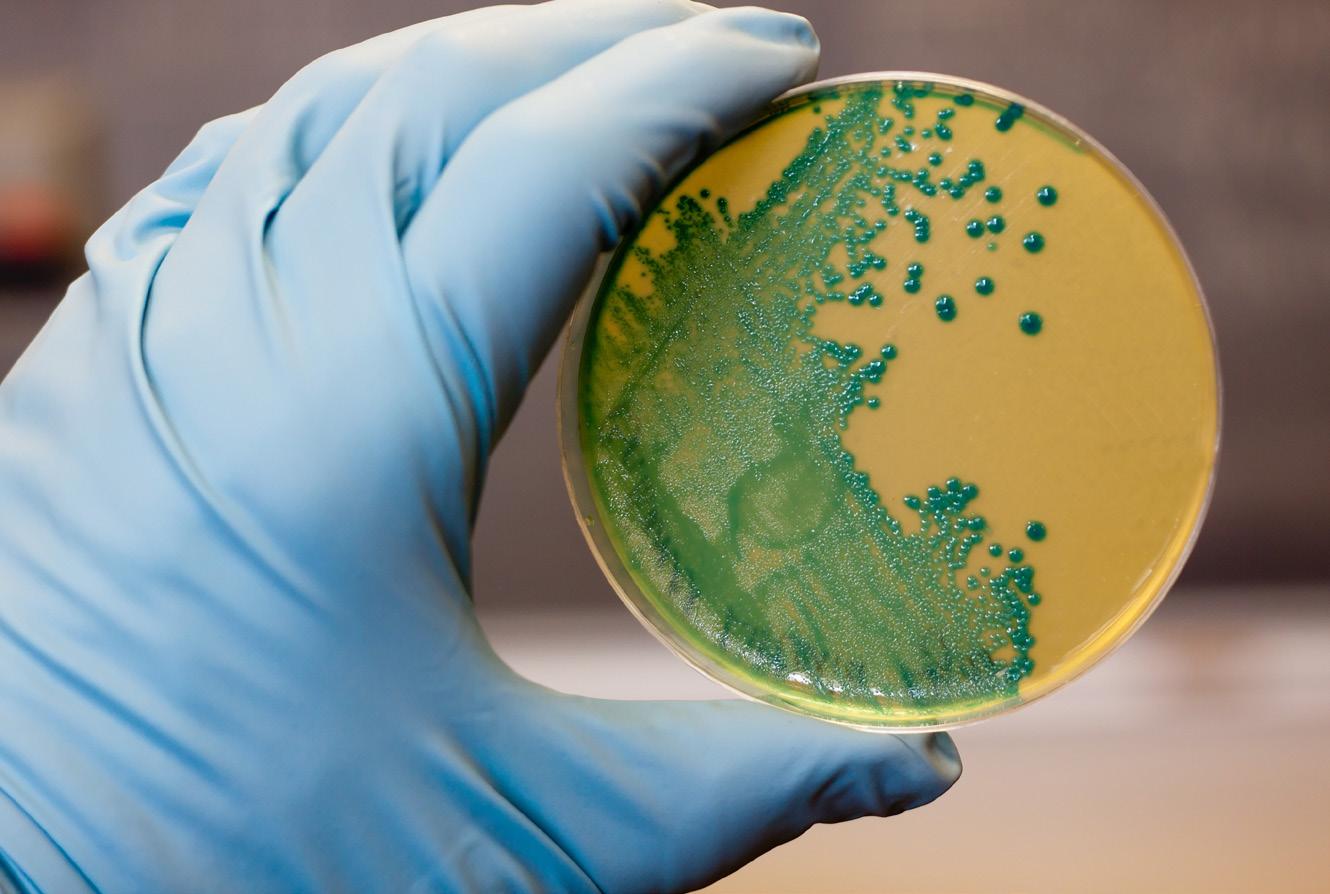

CLEAN, AFFORDABLE POWER Equatorial Guinea models success of US investment in African gas INSIDE: NEW VENTURES VBKOM Mining Engineering & Consulting Africa is unearthing opportunities to improve lives in the mining sector We don’t compete with anyone—we compete with ourselves. We want to be better than we were a year back. It’s a mindset.” ISSUE 6 African news ISSUE 5 R45.00 IN FOCUS FUTURE PIPELINE Why digitalisation offers high returns for emerging gas producers How large miners and states stifle local capital in the DRC





30secondsisallittakesforasmall firetoburnoutofcontrol! Willyourassetssurvive?









Contactustoday! 0119491157 SALES@astafrica.com www.astafrica.com IGS0085
HowSafeisyourbusinessfromfire? ASTnotonlyoffersawiderangeoffireprotection systemsandsolutionsthatmeetyourbudgetandsuit yourneeds,wealsooffercomprehensive consultationsperformedbyqualifiedexpertswith yearsexperience,ensuringthatyouhavethebestfire suppressiontechnologyatyourdisposal.


Your business has something special to offer and our job is to give your customers a way to discover you and your brand online. And still have time for your family
We help you develop your story and your voice and connect with the clients who want to do business with you. We like to talk about your business as much as you enjoy sharing it with others. That means we treat your business like it’s our own. We get down to the nitty gritty and find out as much as we can in an initial free consultation with you where you let us in on the journey you’ve taken up to this point and the goals you have, moving forward. We’ll be actively by your side all the way because your success is our success. Chat with us on WhatsApp Visit our website
Let’s chat about your business!
CONTENTS

ISSUE #6
We don’t compete with anyone—we compete with ourselves. We want to be better than we were a year back. It’s a mindset.
4 African mining news Issue 6
BME provides sustainable solutions and ongoing support that create value across the blasting cycle - for our partners, their workforce and the broader mining community.
BME provides sustainable solutions and ongoing support that create value across the blasting cycle - for our partners, their workforce and the broader mining community.
BME provides sustainable solutions and ongoing support that create value across the blasting cycle - for our partners, their workforce and the broader mining community.

BME, together with Protea Mining Chemicals, forms the mining division within the Omnia Group. The Omnia Group is a JSE-listed diversified provider of specialised chemical products and services used in the mining, agriculture and chemicals sectors. www.bme.co.za
BME, together with Protea Mining Chemicals, forms the mining division within the Omnia Group. The Omnia Group is a JSE-listed diversified provider of specialised chemical products and services used in the mining, agriculture and chemicals sectors. www.bme.co.za
BME, together with Protea Mining Chemicals, forms the mining division within the Omnia Group. The Omnia Group is a JSE-listed diversified provider of specialised chemical products and services used in the mining, agriculture and chemicals sectors. www.bme.co.za
Since 1984, we’ve consistently raised the bar on industry, safety & environmental standards.
FOR EXPLOSIVES, THINK
BME.
Since 1984, we’ve consistently raised the bar on industry, safety & environmental standards.
FOR EXPLOSIVES, THINK
BME.
Since 1984, we’ve consistently raised the bar on industry, safety & environmental standards.
FOR EXPLOSIVES, THINK BME.







CONTENTS ISSUE #6 FEATURES 30 IN FOCUS A burgeoning energy sector: Promoting investment in Zimbabwe 38 OPINION Ghana needs to rethink its small-scale mining strategy 44 LAW Investment laws in Mozambique have been evolving with time to meet international best practices 50 OIL Namibia’s first oil discovery, Shell’s Graff-1 well, is a game changer for the country 58 GAS Equatorial Guinea models success of US investment in African gas 62 MINERALS Travelling through deep time to find copper for a clean energy future 68 RENEWABLE ENERGY Myths and truths around South Africa’s latest renewable energy auction The world, investors and the broader industries are watching how Namibia manages this discovery. 62 38 50 30














Our Executives are: Our Executives are: Our Executives are: Our Executives are: Our Executives are: Our Executives are:



80 HEALTH Zambia must treat children suffering from lead poisoning from mines 86 ENVIRONMENTAL SAFETY How engineered bacteria could clean up oil sands pollution and mining waste 92 SKILLS DEVELOPMENT Japan, Hitachi Construction Machinery and UNIDO to train construction equipment operators in Zambia REGULARS 10 FROM THE EDITOR 12 EVENTS Conferences and meetings for the African mining industry Mining is wasteful and unsustainable, and the industry is in desperate need of effective solutions to treat its large bodies of waste. 74 TECHNOLOGY Mining the moon’s water will require a massive infrastructure investment —but should we? CONTENTS ISSUE #6 86 COMPANY PROFILES Watex Global 20 Spill Doctor 24 DY- Mark Global 26 Trollope Mining 28 8 African mining news Issue 6
Linvar prides itself on matching its great products with exceptional service.





Our team of professionals are available to provide assistance for all customers, from small businesses seeking innovative storage solutions, all the way to manufacturing and warehousing with complex logistics requirements.
We also specialise in supplying and fitting factory, office and warehouse shelving, racking and mezzanine floors. Linvar provides a full range of services including planning, design, and project implementation management.
Our trained advisors have many years of experience within the Storage and Materials handling industry, with a combined knowledge to make sure you get exactly the right product for your needs. They will happily visit you on site to discuss your requirements. We are able to quote you on Drive-in Racking, Decked Racking, Pallet Racking, High Bay Racking, Live Carton Storage, Live Pallet, Mobile and Light-duty Racking.




Johannesburg: 011 608 0250 Cape Town: 021 380 8760 Durban: 031 700 1434 Port Elizabeth: 041 367 1178 East London: 082 441 2939 Get in touch: Download NOWONLINE! www.linvar.co.za The Linvar APP Chat to us on WhatsApp STORAGE& MATERIAL HANDLING SOLUTIONS
We can turn things around
One of the joys of being an editor, or journalist for that matter, is meeting people through the interviews we conduct. And almost always you’re confronted with an opinion that differs from yours. It’s easy to get caught up in the negative side of life. This is particularly true in South Africa where we’re confronted daily with news designed to rob us of our positivity. However, during the interviews I’ve conducted, I’ve met the people at the coalface: CEOs, CFOs, COOs etc. It fills me with the hope that these people are looking beyond the doom and gloom. No, they’re not blind to the reality that is South Africa, but they choose not to drape themselves in sackcloth and ash.

While to some it may sound like blue-sky thinking, it takes me back to my early days in journalism.
Young, naïve and idealistic, it soon became clear there was a clear divide in the newsroom over the issue of ‘sunshine journalism’, or just reporting the good news. Some felt that, as a community newspaper, the ‘hard news’ should be left to the other papers in the company.
The issue was never resolved. Will it ever be resolved? Probably not. Bad news sells, as the saying goes. And while both arguments have merit, it’s nice to see and hear the good news stories.
And that is what I’ve found when interviewing these business leaders. Their positivity and willingness to persevere in the face of adversity gives me hope that, despite the bleak outlook, we can turn things around.
Enjoy the magazine.
10 African mining news Issue 6
THE EDITOR
FROM
From simple to challenging: With radar technology that is highly robust, flexible and economical all at the same time, VEGA is putting things on track to ensure more reliable and efficient production processes involving bulk solids.
Due to our decades of experience we understand the requirements of the industry quite well. That’s why VEGAPULS level sensors are able to deliver exact measured values even when conditions get extreme because of dust, noise or buildup. And why they are also ideal for simple applications where efficiency, and economy in particular, are required.

www.vega.com
Accurate down to the smallest grain. Radar for reliable levels in bulk solids applications
MEET UP
Rub shoulders and conduct business with the highflyers in the African mining industry

EIMS 2022 will bring together global mining companies, investors, solution providers and governments to explore new mining opportunities in the market, introduce their brands, make new connections and create long-term strategic partnerships. It will also offer key insights into the market, in-depth analysis of resources & opportunities, overview of the mineral commodities available, permits & bids, their geological background, reserves and production.
2022 PGMs Industry Day www.pgmsindaba.com/otherindabas/the-pgms-industry-day
For one day only, producers, investors and users of platinum group metals (PGMs) will gather to discuss all things related to PGMs. Join industry experts from different areas of the sector as they unpack critical issues including the current and future potential for PGMs applications, supply and demand fundamentals affecting the PGMs market, and much more. The event will take place online and in person at the Country Club Johannesburg, Auckland Park.



Mines and Money – Online Connect minesandmoney.com/online
Mines and Money Mines Online Connect brings together miners, investors, financiers and industry professionals to network, hear market analysis, compare investment opportunities, share knowledge, discuss, debate and most importantly, do business— all in a virtual and online format. The 72-hour event offers senior management teams of mining companies the opportunity to connect and meet face-to-face with carefully qualified investors from institutional funds, private equity groups, family offices and private investors to discuss project updates and share presentations virtually.
12 African mining news Issue 6
5 TO 7 APRIL 28 & 29 MARCH 6 APRIL
EVENTS
3rd Egypt International Mining Show 2022 – Virtual Connect egypt-mining.com
Africa.
for over 27 years, Mining Indaba has a unique and widening perspective of the African mining industry, bringing together visionaries




innovators from across the spectrum: attracting more junior, mid-tier and major mining companies, more investors and, as always, the largest gathering of mining ministers in Africa. Meet everybody who’s anybody, from the world’s biggest industry giants to tomorrow’s barrier-breaking disruptors —transforming the trajectory of










Presented by Professor Steven Rupprecht from the University of Johannesburg, this learning event will help you with mine design criteria; understanding the mine planning cycle; equipment selection; cut-off grades; risk analysis; the role of environmental, social and governance; and financial technical evaluations, among others.

FN9233 Consolidations South Africa to Zambia and DRC From 1 ton Bakkies to 34 ton Superlinks • Local Collections • Crating and Packaging • Warehousing • Dedicated and Express Loads • BV and FERI facilitation • Customs entries LET US SWEAT THE SMALL STUFF! Cargo 2 Congo Ka Go 2 Go FN9233 Consolidations South Africa to Zambia and DRC From 1 ton Bakkies to 34 ton Superlinks • Local Collections • Crating and Packaging • Warehousing • Dedicated and Express Loads • BV and FERI facilitation • Customs entries LET US SWEAT THE SMALL STUFF! +27 79 569 4248 | +27 11 316 5003 | mike@greendoorlogistics.co.za www.greendoorlogistics.co.za Cargo 2 Congo Ka Go 2 Go Consolidations South Africa to Zambia and DRC From 1 ton Bakkies to 34 ton Superlinks • Local Collections • Crating and Packaging • Warehousing • Dedicated and Express Loads • BV and FERI facilitation • Customs entries Cargo 2 Congo Ka Go 2 Go 23 TO 26 MAY
Mine Planning and Design School (Online) www.saimm.co.za 9 TO 12 MAY Investing in African Mining Indaba is solely dedicated to the successful capitalisation and development
mining interests
your
Investing in African Mining Indaba miningindaba.com EVENTS
of
in
Succeeding
and
business.



PUBLISHER: Donovan Abrahams EDITOR: Ashley van Schalkwyk ashley@avengmedia.co.za CHIEF SUB-EDITOR: Tania Griffin DESIGN: Christine Siljeur CONTRIBUTING WRITERS: African Energy Chamber (www.EnergyChamber.org), Rohitash Chandra, Jo Condon, Julian Diaz, Alex Ellery, Grace Goodrich, Wikus Kruger, Richard Kwaku Kumah, Chido Mafongoya, Dietmar Müller, Office of the UN High Commissioner for Human Rights, Presidency of the Republic of Kenya, United Nations Industrial Development Organization, Leon van der Merwe, Ashley van Schalkwyk, Vikramaditya G. Yadav IMAGES: unsplash.com, pexels.com stock.adobe.com COVER PROFILE IMAGES: Mont Fur Fine Photography PROJECT MANAGER: Viwe Ncapai ADVERTISING SALES: Kay Davids, Rochelle Elias, Randimo Kaylor, Wendy Scullard, Marc Wessels, Mellouise Thomas ONLINE CO-ORDINATORS: Majdah Rogers, Ashley van Schalkwyk ACCOUNTS: Benita Abrahams HUMAN RESOURCES MANAGER: Colin Samuels CLIENT LIASON: Majdah Rogers PRINTER: Print on Demand DISTRIBUTION: www.africanminingnews.co.za www.magzter.com DIRECTORS: Donovan Abrahams Colin Samuels PUBLISHED BY: Aveng Media Boland Bank Building, 5th Floor 18 Lower Burg Street Cape Town, 8000 Tel: 021 418 3090 Fax: 021 418 3064 Email: ashley@avengmedia.co.za Website: www.avengmedia.co.za DISCLAIMER: © 2022 African Mining News magazine is published by Aveng Media (Pty) Ltd. The Publisher and Editor are not responsible for any unsolicited material. All information correct at time of print. THE AFRICAN MINING NEWS TEAM 14 African mining news Issue 6 CREDITS
LIGHTER - FASTER - STRONGER – SAFER
LIGHTER - FASTER - STRONGER – SAFER
LIGHTER - FASTER - STRONGER – SAFER
LIGHTER - FASTER - STRONGER – SAFER
YOUR MINING SCAFFOLDING SOLUTION
YOUR MINING SCAFFOLDING SOLUTION
YOUR MINING SCAFFOLDING SOLUTION
YOUR MINING SCAFFOLDING SOLUTION
Layher is the world’s largest producer of high-quality system scaffolding, with all its material manufactured at the company’s headquarters in Germany. Layher’s Allround scaffolding system is designed with high precision and allows up to eight connection points at the rosette.
Layher is the world’s largest producer of high-quality system scaffolding, with all its material manufactured at the company’s headquarters in Germany. Layher’s Allround scaffolding system is designed with high precision and allows up to eight connection points at the rosette.
Layher is the world’s largest producer of high-quality system scaffolding, with all its material manufactured at the company’s headquarters in Germany. Layher’s Allround scaffolding system is designed high precision and allows up to eight connection points at the rosette.





Layher is the world’s largest producer of high-quality system scaffolding, with all its material manufactured at the company’s headquarters in Germany. Layher’s Allround scaffolding system is designed with high precision and allows up to eight connection points at the rosette.

Based in Johannesburg since 2011, South African subsidiary Layher (Pty) Ltd provides high standards of engineering and service, while ensuring that customers can profit without compromising on safety.
STRONGER STEEL
Layher
components.
LIGHTWEIGHT
By using higher-tensile steel, a thinner material and innovative profiles, our steel decks are up to 43% lighter than carbon steel. This allows for FASTER and SAFER assembly.
HOT_DIP GALVANISED
Layher’s steel components are all manufactured in Germany, and hot -dip galvanised in specialised galvanising facilities – the largest such facilities in Germany! Layher’s hot dip galvanising offers superior protection from corrosion, resulting in a longer service life.
QUALITY
CONTROL
AND
TECHNICAL INFORMATION Technical Data documentation, instructions for Assembly and a pprovals according to EN 10204 and production certified according to ISO 9001: 2008
TRAINING, ENGINEERING AND TECHNICAL SUPPORT







www layher co za
scaffolding uses high tensile steel which provides its components with higher load bearing capacity and allows for the manufacture of lighter

16 African mining news Issue 6 COVER PROFILE
We don’t compete with anyone—we compete with ourselves. We want to be better than we were a year back. It’s a mindset.
NEW VENTURES
VBKOM Mining Engineering & Consulting Africa is unearthing opportunities to improve lives in the mining sector
VBKOM is not your typical professional services
consultancy. In fact, the company doesn’t like to think of itself as a traditional consultant at all. Rather, it sees itself as a client’s strategic partner—dedicated to helping them achieve success while empowering their business to have a positive impact on people’s lives.
VBKOM’s highly skilled and committed area specialists create amazing solutions for each client, making sure their challenges are met with advanced problem solving and implementation approaches that solve their current problems, and make their future successes possible. The company offers services such as mining engineering & consulting, geology consulting, industrial engineering, metallurgical engineering, financial modelling, and project management & -support, among others.
At the helm as CEO is Manie Kriel, a mining engineer by trade. Having been in the industry for many years, he identified that there was a transition taking place in mining, particularly regarding the lack of specialist and scarce skills in South Africa. “Already in the mid-2000s we realised there was a change happening: a number of professionals and qualified professionals in the mining industry were transitioning to a city lifestyle instead of being based in the sticks, the mining towns, the mining destinations,” says Kriel. “In South Africa specifically, if you spoke about consulting and services in mining organisations, companies were always very comfortable utilising the South African consultants when it came to deep-level gold and platinum mine projects—but for some or other reason, when it came to open-pit and open-cast mining, the Australian consultants and the Canadian consultants were more prevalent.”
That was when Kriel and the other founding members saw an opportunity to challenge that situation and position VBKOM
to serve the mining projects in Africa, with the specific focus at that time of open-pit and open-cast mining. “It served our purpose and our vision was clear initially, and the company has gone from strength to strength in terms of that environment and that initial focus.”
The thing that has served the founding members well all these years is their planning, says Kriel. Even before they opened their doors, they spent about six months planning, getting the business plan together and understanding all the risks associated with leaving a secure environment of earning a salary to start a business.
They also made the decision to take on this massive undertaking together as five well-established mining engineers. “Many mining professionals start something on their own, on a freelance basis, but as an individual it’s immensely difficult. We had the fortitude of being five consultants from day one. And then it quickly became seven, eight, nine people in those first two years. And then we immediately had a footprint and that served us well,” Kriel reveals.
Issue 6 African mining news 17 COVER PROFILE
VBKOM was established right on the back of the global financial crisis, so it was tough and there were many challenges—yet, the company survived. “I would subscribe it to the planning, the quality of the five people at the time, and also the fact that from day one we didn’t have to just look at one individual.”

In 2014, two years after the Marikana tragedy, the mining consulting businesses were affected as well, and more recently the COVID-19 pandemic hit. But VBKOM was able to weather these storms and emerge from them stronger and wiser, thanks to the fundamental building blocks the company has constantly put in place.
“We don’t compete with anyone—we compete with ourselves,” says Kriel. “We want to be better than we were a year back. We can never stagnate, we need to continuously challenge ourselves. It’s a mindset.”
It is this growth mindset that has stood VBKOM in good stead over the years. But with the cyclical nature of the mining industry, management quickly realised that it cannot just be growth at all costs—you have to adapt to the environment.

“Our goal is sustainable growth, not to stagnate, not to move back. To sustainably grow our team of highly talented individuals,” says Kriel. “So, to a large extent, the goal is to build a fortress for VBKOM that will survive the greatest storms in terms of the macro-economic environment that we don’t have control over. If we can just be better and stronger every year in terms of our capabilities and skills and also efficiencies, then we are achieving our goals.”
Thanks to this philosophy, today VBKOM continues to be successful. The company has been involved on the Copper Belt of the Democratic Republic of the Congo, from the first pre-feasibility study to the design—and once the mine was constructed, doing the competent persons reports on a constant basis to stay in touch with what was happening there. “It was so satisfactory to walk there and to see that line that I had drawn on the computer screen was now actually a road connecting the pit with the plant, and seeing the number of employed people in a very remote space. A mine like that in the DRC employs about 3 000 people at the end of the day,” shares Kriel.
On the local front, in the Northern Cape, VBKOM was involved in the start-up of a manganese mine. It currently employs more than a thousand people, serving a community near Hotazel and providing the people with a livelihood.
When asked what he enjoys most about working in the mining industry, Kriel says it’s the sheer scale thereof. “It’s enormous, everything is at a massive scale —it’s overwhelming to some extent for an outsider. When we start talking about our industry to people outside of the industry, then we realise it’s really special to work in an industry where you get exposure to technology, to large equipment, to people and human nature and unions... So the variety is really an adventure because there never is a dull moment. It’s multi-pronged, it’s multifaceted. You have to be grounded to always realise that you can’t know everything—but if you have a curiosity and a growth mindset, you will always find your place in mining. There’s always something to discover, there’s always something to grow toward as a person.”
The CEO says the purpose of VBKOM is unearthing the opportunities that the company’s solutions bring in
18 African mining news Issue 6 COVER PROFILE
The CEO says the purpose of VBKOM is unearthing the opportunities that the company’s solutions bring in order to improve lives.
order to improve lives. And they really back their own experience and knowledge and skill set to find those solutions. What it comes down to is having an impact on the communities in which the mines are located—to leave a footprint of job creation in a country like South Africa. “That is the number-one challenge,” says Kriel. “By creating a successful mine, we know that if there are 500 jobs created on that mine, then there are probably about 5 000 secondary jobs created in secondary industries that support mining.”
It gives Kriel and his colleagues much satisfaction in drawing a line on the computer screen in the design phase, to actually seeing the mine being built; appointing people, training them, getting them excited about the new venture, and then ultimately making a difference in people’s lives.
Kriel is also passionate about developing junior miners—another means to improving lives by providing jobs. He believes that if South Africa can ignite the junior mining sector, there will be a great opportunity to unlock further potential in the industry. The issue is so close to his heart that it is the subject of his PhD thesis that he will be completing this year. “The
focus of my research is really a success model for establishing the junior miner, the up-andcoming entrepreneur in the mining industry. I think there are huge challenges for these guys: they are not as effective and not getting traction as I believe they can and should. In South Africa there’s huge opportunity. We’re sitting on a wealth of resources, but we’re underperforming as an industry because we’re not creating a conducive environment for these junior miners.”

Kriel mentions that one of his mentors in his early career while working at Trans Hex Group was the CEO, Llewellyn Delport. Delport entrusted Kriel with the role of general manager of one of the regions, and had regular management interactions. “One thing that stands out for me in terms of those interactions is the fact that he’s one of the smartest people I’ve ever been fortunate to work with. So I think just a simple thing of IQ does weigh heavily, because when he spoke, people listened—it came from a position of being informed and having good experience. What I took from him is that you need to know what you’re talking about when you speak. And his boldness of giving
people opportunities to take on responsibility. You didn’t want to disappoint him because of the leader he was.”
So ever since Kriel has been in management roles, he’s felt the responsibility to also mentor others. He wishes to share the life lessons he’s learnt, imparting some of the knowledge he’s gained along the way to his team so that they don’t “burn their fingers” as he did in the past. “I have an open-door policy. Everyone is always welcome to have a cup of coffee with me, then we exchange thoughts and ideas—that’s the other idea of consulting. We put great emphasis on teamwork and collaboration. So mentorship and coaching is an important part of what we do every day.”
What does the future hold for VBKOM?
After 14 years in business, the company has taken the bold decision to establish an international office within the next three years. This will be in addition to the two existing offices in Centurion and the Northern Cape town of Kathu, which have successfully been serving the whole African continent. “We have realised that because our talent and our team are in such high demand internationally, we would like to put an international option in place. We’re excited by that prospect, continuing to improve on our sustainable model. We’ve invested heavily in our processes of recruiting and finding highly talented individuals,” says Kriel. “It’s taking the big step out of our comfort zone, which is Africa, and going international.”

Issue 6 African mining news 19 COVER PROFILE
QUALITY PRODUCTS
ON TIME, EVERY TIME
Reinforced Hosing, manufacturer of Watex hose products, has became a major force in the hardware industry

20 African mining news Issue 6 COMPANY PROFILE
quality
It was back in 1999 that Gavin Brown and Dev Howett established Reinforced Hosing to fill the gap left by the closure of Illmans Plastics and Saplex Industries. The fledgling company faced many challenges, particularly around product quality and growing a customer base.

But with hours of hard work and planning, Reinforced Hosing rapidly became a major force in the gardening sector of the hardware industry.
Reinforced Hosing was listed by Pick n Pay, and soon the first orders of Watex garden hoses were filtering into the group nationally. Today, after more than 20 successful years, Watex is a household name in the garden hose business and can be found on the shelves of many supermarkets, hardware stores, nurseries, and others.
Reinforced Hosing manufactures PVC hoses —from garden hoses to agricultural dragline, gas, mining, suction, multipurpose, fire, fuel, oxy and acetylene and clear tubing (see sidebar). All products are produced from virgin materials that have a UV protection additive to deal with the harsh climatic conditions prevalent in South Africa. Also available is a top-quality range of Watex hose-end fittings.
PRODUCTS ON OFFER
Garden Hose & Accessories
• Tap adaptors
• Sprinklers
• Sprayers
• Hose menders and joiners
• Hose connectors
• Pyramid sprayers
• Green wall vertical garden system
• Garden hose
• Builders hose
• Hose hangers
Agricultural Hose

• Crop spray hose
• Dragline hose
Industrial Hose
• LP gas hose and regulators
• Acetylene and oxygen hose
• Air and water hose
• Clear reinforced tubing
• Clear thick/thin wall tubing
• Fuel reinforced hose
• Multipurpose hose
• Fire hose
• Suction hose
Mining Hose
• Anti-static hose
• Anti-static loading hose

• Standard/medium/heavy duty mining hose
• Rockdrill hose
Project
has remained a major focus over the years.
Issue 6 African mining news 21 COMPANY PROFILE
Watex CEO, Gavin Brown
The company is proud to have SABS certification on its mining and gas hoses, which are manufactured to SANS 1086:2007 and SANS 1156-2:2012 quality standards respectively.

Project quality has remained a major focus over the years. CEO Brown employed the services of Tim Niemand, whose expertise spans more than 50 years. Niemand introduced a superb adhesion formulation which, together with other innovative research, put Watex on par with—if not better than—most international brands. “Our quality is of the best available in South Africa, and we continually strive to improve an already top-class product,” adds Niemand.
Brown explains that when the exchange rate favours the dollar, there is a plethora of cheap imported hose entering the market and which undersells the Watex brand in large quantities. “But our saving grace is that the quality of these products is inferior to our Watex brand.
Although the import threat is very real, many of our dealers remain loyal to the brand and quality, while others tend to buy on price alone.”
The CEO ascribes the company’s ongoing success to multiple factors, top of which is its ability to deliver a quality product on time, every time. In addition, within its first 10 years of existence, Reinforced Hosing identified further growth areas to ensure its future, branching out into the mining sector and the rest of the African continent—becoming wellrepresented in countries such as Zimbabwe, Zambia and Botswana, among others.

When the Dragline range showed exponential growth, the company realised the farming community was an important player in the irrigation sector, and made a huge effort to rapidly increase its share of this market, Brown reveals.
It is the goal of Reinforced Hosing to remain a local manufacturer supporting local business and creating employment for South African people, thereby adding value to the economy.
Contact details
Address: Cnr Aschenberg & Davis Street, Chamdor, Krugersdorp 1739
Tel: 011 769 2600 Email: info@watex.co.za www.watex.co.za
22 African mining news Issue 6 COMPANY PROFILE
The CEO ascribes the company’s ongoing success to multiple factors, top of which is its ability to deliver a quality product on time, every time.











WATEX REINFORCED PVC MINING HOSES COMPLY WITH SANS 1086/2007 AND ARE DESIGNED FOR AFRICAN MINING CONDITIONS AND HAVE A WIDE RANGE OF APPLICATIONS. WATEX MINING HOSE APPLICATIONS: • Jack Hammers • Compressors • Pneumatic Tools • Air & Water Conveyance • Excellent Cut & Abrasion Resistant • Oil & Diesel Resistant • Lightweight & Flexible WATEX Yellow Heavy Duty super flexible mining hose, suitable for colder conditions. Operating temperature -10O C to +50O C. PRODUCT CODE: RMY10030 RMY12030 RMY20030 RMY25030 RMY32030 RMY40030 RMY50030 Nominal ID (mm) 10 12 20 25 32 40 50 Burst Pressure Kpa 6800 6800 6000 5600 4000 3500 3500 Working Pressure Kpa 1700 1700 WATEX Green Heavy Duty super flexible mining hose, suitable for colder conditions. Operating temperature -10O C to +50O C. PRODUCT CODE: RMG10030 RMG12030 RMG20030 RMG25030 RMG32030 RMG40030 RMG50030 Nominal ID (mm) 10 12 20 25 32 40 50 Burst Pressure Kpa 6800 6800 6000 5600 4000 3500 3500 Working Pressure Kpa 1700 1700 1500 1400 1000 900 900 WATEX Blue Heavy Duty super flexible mining hose, suitable for colder conditions. Operating temperature -10O C to +50O C. PRODUCT CODE: RMB10030 RMB12030 RMB20030 RMB25030 RMB32030 RMB40030 RMB50030 Nominal ID (mm) 10 12 20 25 32 40 50 Burst Pressure Kpa 6800 6800 6000 5600 4000 3500 3500 Working Pressure Kpa 1700 1700 1500 1400 1000 900 900 WATEX Orange Heavy Duty super flexible mining hose, suitable for colder conditions. Operating temperature -10O C to +50O C. PRODUCT CODE: RMO10030 RMO12030 RMO20030 RMO25030 RMO32030 RMO40030 RMO50030 Nominal ID (mm) 10 12 20 25 32 40 50 Burst Pressure Kpa 6800 6800 6000 5600 4000 3500 3500 Working Pressure Kpa 1700 1700 1500 1400 1000 900 900 WATEX-MRD Red Rockdrill Hose. Heavy Duty Ultra High Pressure Hose. Operating temperature -0O C to +50O C. PRODUCT CODE: MRD12030 MRD25030 MRD50030 Nominal ID (mm) - 12 - 25 - - 50 Burst Pressure Kpa - 10000 - 8000 - - 4500 Working Pressure Kpa - 3000 - 2000 - - 1125 WATEX - Anti-Static Loading Hose. Anti-Static and Semi conductive, complies with SANS 2878:2011 PRODUCT CODE: RMA16030 RMA20030 Description Nominal Internal Diameter (mm) Nominal Internal Diameter (mm) ATS - Smooth ID 16 20 OD 24 Max 29 Max ATR - Ribbed (Heavy Duty) 20 25 Reinforced Hosing (Pty) Ltd Website: www.watex.co.za • email: info@watex.co.za • Tel: +27(11) 769 2600 QUALITY HOSE MANUFACTURER





MAKE YOUR MARK
As the African mining industry continues to experience rapid growth, so too does the need to keep up with the latest and greatest products available on the market. The market is full of marking and survey paints, so how do you know you’re getting the best bang for your buck? Sure, there are plenty of cheaper

imports available that offer just that: a cheap inferior product that’s short-lived and needs to be reapplied too many times.
Unfortunately, saving money doesn’t always mean fewer expenses and frustrations. A simple marking and identifying task can take double the time if using low quality products that predictably
clog and spit. On the other hand, using a higher quality marking paint can provide highly visible and longlasting marks even in dark areas.
Dy-Mark’s Mine Marking and Mine Marking Non-Flammable aerosols have been specifically designed for use in mines and excavation sites—with both products available in horizontal
Dy-Mark’s Mine Marking paints are formulated to be as tough as the environment they are used in
26 African mining news Issue 6 COMPANY PROFILE
and inverted (trigger) formats. The horizontal format is suited for spraying rock walls and faces, while the inverted (trigger) format is suitable for marking on the ground and on mine ceilings.


Dy-Mark Mine Marking is widely recognised as a quality product and has been used for marking out ore zones in grading control,
pit walls and survey grid layouts. Mine Marking Non-Flammable marking paint is specifically designed for use in coal mines and other fire-sensitive situations.

Both Dy-Mark Mine Marking and Dy-Mark Mine Marking NonFlammable have proved to be popular in mines throughout the SADC countries, Australia, Chile, Turkey, Indonesia and Papua New Guinea. Mine Marking and Mine Marking Non-Flammable have been formulated to give bright, highly visible marks, ideal for dark mining environments. Both paints will mark on rock, dirt, gravel, asphalt and other surfaces.
Formulated to be as tough as its environment, Dy-Mark’s Mine Marking paints overcome the exceptional darkness and distance factors faced in mining. Specially engineered with the market’s needs in mind, Dy-Mark’s Mine Marking paint delivers an easy-to-use, highly visible and long-lasting product.
Not only has Dy-Mark developed these distinct marking paints but has also brought to the market an extendable Mine Marking Handle, suitable for use with both Mine Marking and Mine

Marking Non-Flammable vertical cans. Specifically designed for marking mine ceilings, this three-part handle extends up to five metres. Available in lightweight aluminium, the handle is constructed to reach inaccessible areas. Reducing back strain and fatigue, the Mine Marking Handle is becoming a welcomed product in mines across Africa.
With over 50 years of experience, Dy-Mark has become one of Australia’s leading manufacturers of a range of specialised marking, coating and packing products. The DyMark range includes marking paints and inks, protective metal coatings, marking pens and aerosol lubricants and cleaners. These products are widely used in several industries, both in Africa and internationally. Dy-Mark offers a complete solution for all your mine marking needs with convenient, easy-to-use and high-quality products.

Built to last, Dy-Mark’s Mine Marking range features the products of choice if you’re after quality products that are just as tough as their environment.

Issue 6 African mining news 27 COMPANY PROFILE
Formulated to be as tough as its environment, DyMark’s Mine Marking paints overcome the exceptional darkness and distance factors faced in mining.
QUALITY WORKMANSHIP
Trollope Mining Services has enjoyed a sound working relationship with several well-known mining companies over the last three decades

Trollope Mining Services (Pty) Ltd is a Level 2 BBBEE rated company that is 26% black-owned and provides the services of opencast mining, crushing & screening, civil infrastructure and rehabilitation while operating in the civil and mining industries.
Established in 1975, the company boasts a substantial fleet of equipment and, although traditionally operations were predominantly based in the coal sector, current operations have extended into platinum, andalusite, gold, phosphate, manganese, limestone and diamonds with strategic intent being to diversify into other mineral sectors and grow its geographical footprint into Africa. The company is currently operating in Botswana and has experience of projects in Guinea and the Democratic Republic of the Congo.
Currently employing just over 2 000 people, Trollope Mining Services has enjoyed a sound working relationship with several well-known mining companies over

the last three decades—including Exxaro, Universal Coal, Mbuyelo Coal, Kangra Coal, Rhino Minerals, Northam Platinum, Pilanesberg Platinum, Kropz, Lucara, Anglo American and BHP Billiton.
Being a privately owned entity, Trollope Mining Services operates on good sound corporate practices and is recognised for delivering a superior service in the mining sector and services industry as a medium to large contractor, always at the highest levels of production and safety. With its focus being customer-orientated and performance-driven, the company prides itself on the quality of workmanship on operations.
Its core philosophy is “Business is about people”. Much time and money is invested in employees and the communities in which the company operates. This is done through various mechanisms such as external and internal training, learnerships, social economic development programmes, and charity fundraising events.
Trollope Mining Services currently has mining operations in the following sectors: energy (thermal coal and coking coal); base metals (manganese and chrome); precious metals/gemstones (diamonds, gold, palladium, platinum, rhodium and silver); and agriculture/construction material (limestone and phosphate). The company also completed operations in the industrial/ chemical sector, mining fluorspar and andalusite.
Its other services include:
• Opencast mining;
• Bulk earthworks;
• Plant hire;
• Crushing & screening;
• Material handling;
• Drilling & blasting; and
• Rehabilitation
Contact details
Address: Farm Elandsfontein 412JR, R25, Ekurhuleni, 1464
Tel: +27 (0)11 281 6000 Email: admin@trollopegroup.co.za
Trollope Mining Services delivers a superior service in the mining sector and services industry
28 African mining news Issue 6 COMPANY PROFILE



























POWER PLAYER A burgeoning energy sector: Promoting investment in Zimbabwe 30 African mining news Issue 6 IN FOCUS




Committed to promoting pan-African investment opportunities, NJ Ayuk, executive chairperson of the African Energy Chamber, conducted a working visit to Zimbabwe at the end of last year to open a dialogue on the country’s promising energy sector. Meeting with Emmerson Mnangagwa, President of Zimbabwe, and presenting his recently published book, Billions at Play: The Future of African Energy and Doing Deals, Ayuk emphasised Zimbabwe as a top investment priority, driving development across multiple energy sectors. Ayuk’s meeting with President Mnangagwa focused on Zimbabwe’s energy potential and delineated strategies by which this potential can be achieved.

Across the country, power generation and transmission remain some of the most critical investment opportunities, as existing coal-fired power stations require upgrades, and untapped natural gas and renewable resources lack exploitation. Therefore, Zimbabwe is seeking new investors and projects to increase installed powergeneration capacity, diversify its domestic energy sector and boost country-wide energy security.
 NJ Ayuk presents his recently published book to Zimbabwe President Emmerson Mnangagwa
NJ Ayuk presents his recently published book to Zimbabwe President Emmerson Mnangagwa
Zimbabwe’s coal reserves have the potential to address energy supply challenges and meet demand across the region.
32 African mining news Issue 6 IN FOCUS
With approximately 30 billion tonnes of coal in 21 known deposits that could have a lifespan of over 100 years,

Currently, the country’s largest thermal power station, Hwange Thermal Power Plant, has a capacity of 750MW, supplying critical electricity to the population. However, with ageing power plants requiring upgrades and the country opting to reduce its reliance on coal, alternative power-generation solutions are being considered and significant investment opportunities have emerged.


Ayuk’s visit initiated a dialogue on one of the country’s most promising sectors: renewable energy. Zimbabwe is home to impressive hydropower potential—estimated at
18 500 GWh per year, of which 17 500 GWh is technically feasible—and aims to drive further investment and associated development to establish domestic energy security and independence. To date, only 19% of the country’s hydropower potential has been exploited, with most of Zimbabwe’s electricity supply produced at the 750MW Kariba Dam Hydroelectric Power Station. With further potential from the Zambezi River, as well as several small-scale prospects across the country, the resource could potentially position the country as a regional renewable competitor.
Image:
www.hararepost.co.zw
34 African mining news Issue 6 IN FOCUS


















Monitor Data Analytics & AI Predictions Diagnostics Digital Twin Data Inputs Improvement Predictions Analytics Diagnostics Monitor Health Production Revenue Safety A company of the SCHAUENBURG International Group www.schauenburg.co.za Schauenburg Systems (Pty) Ltd 26 Spartan Road, Spartan Ext,21 Kempton Park, 1619 Tel: +27 (11) 974-0006 Email: sales@schauenburg.co.za Lamproom Management Solutions Environmental Monitoring Solutions SmartConnex Gas Detector and Communication GDI Sentinel GDI SmartWear+ GDI SmartWearV GDI Viro-Cap Collision Avoidance Solutions LED Caplamps ROXY 40 SCSR AUTO CONNECT • Multiple Gas • Man-down • Panic • Dust + Noise Integration • Location SAFE • Actionable Information • Real Time Connection (WiFi/BLE) • Location-based Events • Interconnected Eco-system • Android App Support SMART • Easy to Understand • Electronic Reports • Interactive Dashboard • Intuitive App Interface • Auto-feature Updates SIMPLE SmartMine Safety Solutions DATA TRANSFORMED INTO ACTIONABLE INFORMATION
Furthermore, Zimbabwe holds significant exploration opportunities for stakeholders. Despite the lack of proven oil and natural gas reserves—and the continued dependence on crude imports to supply the nation— Zimbabwe is redirecting its focus on exploration, specifically of natural gas. Having experienced critical electricity shortages for decades, Zimbabwe is seeking alternative powergeneration solutions, in which natural gas may be a viable alternative. The southern African nation is pursuing partnerships and investment deals with international stakeholders, focusing on accelerating exploration and driving energy sector diversification and growth. Meanwhile, according to the International Trade Administration, Zimbabwe’s lithium deposits are the largest in Africa. With the rapid increase in global demand given the mineral’s importance to the energy-battery industry, the country has the potential to become a major exporter, while contributing to the global energy transition.
To position itself as a clean energy player, Zimbabwe requires significant investment in mining, with additional opportunities available in mining supplies, transportation infrastructure and materials. In a bid to attract further investment, the government has proposed regulatory changes to the Mines and Minerals Act, making it more progressive and investor-friendly. With a renewed interest in increasing domestic production, the government is seeking significant capital investments.
“With established sectors requiring upgrades, and emerging sectors seeking international participation and investment,


the country offers significant potential for both regional and international players,” stated Ayuk. President Mnangagwa has declared a commitment to developing a robust energy sector in Zimbabwe to meet rising power demand brought about by an increasingly vibrant, productive and resilient economy and people. With significant potential across multiple segments of its energy economy, Zimbabwe hopes to attract both regional and international investment, utilising its energy sector as a catalyst for wider socio-economic growth.
African Energy Chamber (www.EnergyChamber.org)
36 African mining news Issue 6 IN FOCUS





POTENTIAL SHIFT

Ghana needs to rethink its small-scale mining strategy. Here’s how
Ghana is among the top two gold producers in Africa (bit.ly/3f9dy9i). What has caught little attention, however, is the fact that more than 35% of total gold output in Ghana comes from artisanal and smallscale miners (bit.ly/3f7lsjz). Artisanal and small-scale mining is estimated to support the livelihoods of some 4.5 million Ghanaians, about 12% of the population (bit.ly/3HJXRSc). They account for more than 60% of the country’s mining sector labour force (bit.ly/3HP182H).
Artisanal and small-scale mining is a low-tech, indigenous and often informal. It occurs in over 80 mineralrich developing countries. Up to 100 million people globally work in this sector (bit.ly/3GfkXzT).

38 African mining news Issue 6 OPINION





@ZiboneleFM_98.2 t @ZiboneleFM98_2 Zibonele FM 98.2 076 551 5915 Studio Line 2 021 361 8962 Studio Line 2 021 361 2105 Station Number: 021 361 7109
Artisanal and small-scale mining has a long history in Ghana. It was only in 1989, however, that the government recognised its legitimacy (bit.ly/3G6N9VD) through the Small-scale Mining Act (PNDCL 218), later integrated into the current Mining Act 703 of 2006 (bit.ly/3r9SqFQ). The act provides a blueprint for its formalisation. It also reserves small-scale mining for Ghanaians. The law requires prospective local miners to apply for a licence to mine up to 25 acres of land in designated areas.

The government’s intention to formalise the sector has had very little success. More than 85% of all small-scale mining operations in Ghana are carried out by unlicensed operators (bit.ly/3r1FxNU).
Due to the sector’s evolving nature, the distinction between artisanal and small-scale mining has become contentious and blurred. To avoid any complications, most scholars now use them interchangeably. Some use the level of sophistication employed to make a distinction. But in Ghana today, one sees rudimentary tools (traditional artisanal mining) and modern tools (small-scale mining) being used on a single mining site.
Jackboot approach
The government’s response to illegal mining has been to use the military to raid small-scale miners. There is a long history to such a combative approach in Ghana. It dates as far back as the British colonial administration, which enacted the Mercury Ordinance of 1933 (bit.ly/3JXRpcs) to ban and criminalise native miners.
In 2013, then president John Mahama formed the InterMinisterial Taskforce to ‘flush out’ illegal miners, which led to many arrests and the expulsion
of illegal Chinese miners. The use of force intensified under the current president, Nana Akufo-Addo, who vowed in 2017 to put his presidency on the line to fight illegal mining in Ghana. This culminated in the setting up of Operation Vanguard (bit.ly/334NKJd), the largest centralised military-police joint task force to combat illegal mining in Ghana.

The real problem, however, is the government’s failure to implement its legislative framework for the formalisation of small-scale miners.
Images: www.miningmx.com, www.modernghana.com
The real problem is the government’s failure to implement its legislative framework for the formalisation of small-scale miners.
40 African mining news Issue 6 OPINION
We do integrated mining

















As mining solutions architects, Ukwazi is able to seamlessly integrate key activities and disciplines across the mining value chain. Partner with our specialist teams and industry experts now, and achieve a cost profile that is compliant, efficient, sustainable and safe to operate.









Public Reporting Project Management Project Development & Delivery Mine Valuations Mining Studies Permitting Solutions Techno-Economic Assessments Sustainable Mining Onsite Services
Barriers to formalisation
The government first introduced a framework for the formalisation of small-scale miners more than 30 years ago. But it has very little to show for it. Less than 15% of smallscale mining operators have been able to acquire the requisite mining licences. Many do not bother to apply due to the tedious and cumbersome nature of the regulatory process.
To gain a better understanding of why the formalisation process has not achieved much, an aspect of my PhD research (bit. ly/3r674xy) sought to unearth local perspectives on the underlying conditions for the creation of these informal local mines. It examines how these underpin persistent informality.
There are two problems. The first is that the current formalisation blueprints fail to adapt to the conditions of the majority of local miners. The second is that the blueprints make it very difficult or too costly for small-scale miners to comply. They are therefore a disincentive to formalise.
Only a small segment of smallscale miners can raise the amount of money required to become formal operators (bit.ly/3GciZjX). The costs include application fees as well as the money required for the preparation and processing
of the application. Then there are costs for environmental permits, the hiring of surveyors and for the acquisition of business documents. A prospective smallscale mining licensee could spend at least US$4 000 to secure the requisite legal status.
When unofficial payments (bribes) are included, according to small-scale miners, the costs of getting a licence to mine 25 acres can balloon to as much as US$7 000. A burgeoning body of research (bit.ly/3Gbciyo) has shown that artisanal and smallscale miners in Ghana are driven to mining by poverty.
The second challenge revolves around a centralised bureaucracy and lack of effective engagement with all stakeholders. Despite the administration of small-scale mining being decentralised into nine mining districts across the country, only the national head office can issue a smallscale mining licence. Key local stakeholders like municipal and district assemblies with better understanding of the complexities play no effective role in the licensing process.
Again, the creation of a centralised task force to address a localised problem runs parallel to existing local structures. This undermines effective policing, monitoring and accountability.
Finding solutions
President Akufo-Addo’s call for a dialogue on illegal mining in his January 2021 State of the Nation address (bit.ly/3ncoVSj) portends a potential shift.
To create the enabling policy environment for a blooming artisanal and smallscale mining industry that is environmentally sustainable and economically beneficial to the state and citizens, greater engagement with local actors is the path to chart.
The solution is the devolution of small-scale mining decisions to municipal and district assemblies working in collaboration with traditional authorities. This will facilitate greater recognition and inclusion of local actors in the licensing process. It will also open dialogue with local miners, since municipal and district assemblies are the local development agents. This will bring decision-making processes closer to smallscale miners and enhance the effective policing and monitoring of the sector.
The reform of the licence regime for small-scale mining should be driven by the need to match the costs of formalisation with the complex socio-economic dynamics of the majority of operators. This is attainable when policy treats small-scale mining as a survivalist sector rather than a platform for wealth creation.
Artisanal and small-scale mining has also suffered because of its portrayal by the media and public misrepresentation as a vehicle for ‘quick money’.

42 African mining news Issue 6 OPINION
Richard Kwaku Kumah PhD Candidate School of Environmental Studies Queen’s University, Ontario




BUSINESS BOOST
Investment has played a pivotal role in the economic development of Mozambique. It has been recorded that the country has been one of the ‘fastest-growing economies’ on the African continent for the last two and a half decades, wherein it has outdone both regional and global growth averages with its rich oil and gas reserves that have been a magnet for major investments from various countries across the world (bit.ly/37hWJVU).
Investment laws in Mozambique have been evolving with time to meet international best practices. The main law that governs national and foreign investments is Mozambique’s Law on Investment, No. 3/93, passed in 1993. Its related regulations in August 2009, Decree No. 43/2009 replaced earlier amendments from 1993 and 1995, providing new regulations to the Investment Law. This article will give an overview of the new regulations.

Mozambique has outdone both regional and global growth averages with its rich oil and gas reserves that have been a magnet for major investments
Investment laws in Mozambique have been evolving with time to meet international best practices
44 African mining news Issue 6 LAW

Mozambique’s Law on Investment puts in place the requisite regulatory framework to promote foreign direct investments (FDIs). FDIs in Mozambique have been anchored by two mega-projects, namely the Mozal aluminum smelter established by mining giant BHP Billiton, and the Temane gas field developed by petrochemicals firm Sasol. These projects pioneered the way for other megaprojects, as they proved that Mozambique was investorfriendly. Sizeable investments in the agriculture and tourism sectors followed as a result of investor confidence in the country.
The Mozambican Investment Law Regulation has been amended by Decree no. 20/2021, which entered into force on 13 April 2021. With the aim of adapting national and foreign investment processes (“investment projects”) to a new institutional framework of co-ordination and in the context of a policy to attract and facilitate those investments, Decree no. 20/2021, of 13 April (“Decree”), was approved, introducing amendments to the Investment Law Regulation.

Below are the some of the major highlights of the amendments:
1. For the purposes of transferring profits abroad and reexportable invested capital, the minimum value of FDI through the allocation of own capital shall now be MZN 7.5 million, and the minimum value for annual exports of goods or services shall be increased to MZN 4.5 million.
2. The initial investment to be made in the first two years of activity by companies established outside Industrial Free Trade Zones, but that wish to benefit from the respective regime, will now have a minimum amount equivalent to MZN 75 million.
3. The Agency for the Promotion of Investment & Exports replaces the Investment Promotion Centre and the Office of Economic Zones for Accelerated Development as the entity responsible for the development, promotion and management of investment projects, as well as the promotion of national exports.
4. As regards the entities responsible for the approval of the investment projects, we note the following:
• Secretaries of State in the Province: for national investment projects in an amount not exceeding the equivalent to MZN 4.5 million;
• Director General of APIEX: Investment projects in an amount not exceeding the equivalent to MZN 7.5 billion and projects under the Special Economic Zone and Industrial Free Zone regimes;
• Minister that oversees the area of Finances: Investment projects in an amount not exceeding MZN 37.5 billion;
• Council of Ministers: Investment projects in an amount exceeding the equivalent to MZN 37.5 billion.
5. The transfer of an investor’s position, including in undertakings and units of the Integrated Tourism Resort Zone, shall now only be subject to authorisation by the entity that authorised the respective project and upon proof of compliance with the relevant tax obligations.
6. Investment project proposals must be sent to the Mozambican Agency for the Promotion of Investment and Exports in four copies, drafted in the official application form, and accompanied of the documents needed for the analysis. Depending on each case, the investment project proposals shall be accompanied of documents as lease contracts, property titles or professional internship and Mozambican workforce employment plans (for local content purposes). Decisions from the Provincial Secretary of State, APIEX General Director and Finance Minister shall be performed until three workdays after the reception of the proposal and APIEX shall inform the investors of the decision, until 48 hours after it.
7. Investors may assign totally or partially their rights regarding an investment, through duly based request to the entity that approved the project. The request shall be accompanied of tax compliance proofs.
8. Companies with headquarters in Economic Special Zones need to request authorisation to hire foreign employees and shall register them with the entity that supervises the employment sector.
46 African mining news Issue 6 LAW
Work with us in 2022
is a black owned legal practice with over 10 years experience in Labour Law, Litigation, Compliance; and driven by values of excellence, empowerment, evolution, ethics and sustainability.




Scan the QR code to meet your team of warriors of the law

9. Approved investors have access to a permanent residence authorisation, which may be extended to their partner and children up to 21 years old.
10. Transfers to foreign territory of profits and dividends are permitted, since the exchange legislation and the payment of taxes are complied.
11. The certification of companies operating in Economic Special Zones is made through the issuance of the competent certificate by APIEX, on 10 workdays after the reception of the request.
12. Inspections to companies with headquarters in Economic Special Zones need a previous authorisation by APIEX and shall be informed to those companies by this entity until five workdays after receiving the inspection request, except when the inspecting authority is the Tax Authority or the Economic Activities National Inspection.
13. Industrial Free Zones are created by decision of the Ministers Council, after proposal of the Finance Minister. APIEX shall analyse the proposal and elaborate an opinion to be analysed by the Ministers Council, and investors have six months after the authorisation date to establish their enterprise in the Industrial Free Zone.

14. The percentage of authorised sales to the local market from companies established in Industrial Free Zones may be modified by the Finance Minister, after founded request by the investors and positive opinion from APIEX and Tax Authority.
15. Claims related with investment matters regulated by the Investment Law and Regulation need to be sent to APIEX, which distributes them by the defendant authorities. If the defendant authorities do not answer APIEX nor execute any measure to solve the claim, APIEX shall propose a solution to the Finance Minister, which will decide the question.
In conclusion, the amendments were intended for the main purpose of aligning it with the new investment institutional framework. It is also in line with investment-friendly policies that the country has been diligently pursuing. The regulations therefore encourage national and foreign investment in the country, which further encourages a significant boost in investments. It is advisable that investors take note of the new regulations and ensure they are complaint with the same when they invest in the country.
Images: www.nsenergybusiness.com, www.south32.net
 Leon van der Merwe and Chido Mafongoya Centurion Law Group
Mozal aluminium smelter established by mining giant BHP Billiton
Leon van der Merwe and Chido Mafongoya Centurion Law Group
Mozal aluminium smelter established by mining giant BHP Billiton
48 African mining news Issue 6 LAW
Temane gas field developed by Sasol
Knowledge is power
Products and solutions

FREE access to three days packed with strateic conference sessions and technical workshops. Networking Join facilitated matchmaking to help connect you with the right contacts as well as dedicated networking areas, meet and greets and social events.
Gain
Connect with the world’s leading products and services providers, from across the power, energy and water value chain, all under one roof. SAVE THE DATE 7 - 9 June 2022 CTICC, Cape Town, South Africa Formerly Your inclusive guide to the energy transition. enlit-africa.com Host publication Created by REGISTER TO ATTEND at www.enlit-africa.com
A NEW DAWN
Namibia’s first oil discovery is a game changer for the country

50 African mining news Issue 6
OIL

Issue 6 African mining news 51 OIL
In February this year, oil and gas giant Shell made an oil discovery in the Graff-1 well located in Block 2913A in the Orange Basin, offshore Namibia (270 kilometres from the town of Oranjemund). Along with partners QatarEnergy and the national oil company of Namibia, NAMCOR, the well was spud in December 2021, using the Valaris-owned DS-10 drillship.
NAMCOR announced at the beginning of February that the Graff-1 deepwater exploration well had made a discovery of light oil in both primary and secondary targets. The oil companies are now performing extensive laboratory analyses to gain a better understanding of the reservoir quality and potential flow rates achievable.


“We hope that this discovery puts to rest doubts about the hydrocarbon potential of Namibia and opens a new dawn in the country’s future prosperity,” said managing director of NAMCOR, Immanuel Mulunga.
The African Energy Chamber spoke to Frank Fannon, former United States Assistant Secretary of State for Energy Resources and current managing director of Fannon Global Advisors, about the significance of Namibia’s new oil discovery.
Fannon was the recipient of the 2021 AEC Lifetime Achievement Award during last year’s African Energy Week in Cape Town for his strong support of the African energy sector and making energy poverty history.
Images: www.offshore-energy.biz, NAMCOR 52 African mining news Issue 6 OIL
LE South Africa celebrates 50 years of reliability solutions

Lubrication Engineers (LE) South Africa celebrates its 50th birthday in 2022 – a major milestone for the company, which has now been family-run for three generations. The company is celebrating 50 years of providing specialist lubrication products and reliability solutions to the local market, and plans to continue expanding its coverage and entering new markets.
Lubrication Engineers was first founded in 1951 in Fort Worth, Texas. LE South Africa was established in 1972 and was the first international distributor of LE products outside of the USA. Today, LE offers distribution in more than 60 countries worldwide. LE South Africa holds the rights for LE products in sub-Saharan Africa and remains one of the top five LE distributors globally by product volume.
“We believe the secret to the business’s longevity is the fact that LE has always focused on designing products that meet the needs of specific applications,” says Callum Ford, National Marketing Manager at LE South Africa. “That, coupled with our product quality, customer service and the fact that we focus on creating total reliability solutions for our customers, is what has seen us continue to grow for 50 years.”
Ford adds that LE also has a deep understanding of its customers’ requirements, the challenges they face and the trends that affect their industries, which has allowed it to

lubricants and general greases) to meet changing needs. This has included developing environmentally-sensitive products, specialist lubricants (such as food-safe options for the food, beverage and agricultural sectors), as well as complete lubrication storage and handling systems, automated lubrication dispensing solutions and reliability programmes, among others.
“
monitoring
“While it’s gratifying to be able to celebrate 50 years in business in 2022, we’re not resting on our laurels,” says Ford. “We continue to grow our team of lubrication specialists and tribologists (we’re currently setting up a presence in the Northern Cape, for example) and extending our reach into the farming and marine sectors, as well as other specialist fields. We hope to be successfully serving our customers for many decades to come.”
For more information, visit www.lubricationengineers.co.za.
Condition
practice is gaining more traction and is of high value to our customers and their industry needs.”
What are your thoughts on this discovery, and what will it mean for the country’s energy sector?
This discovery is a game changer for the country. Namibia has had 40 plus years of uneconomic or dry holes since the Kudu gas field discovery in 1974. Shell’s new Graff-1 well confirms to the global industry that Namibia has the resources to attract the world’s best and brightest.
What advice would you give to Namibia on how to handle exploration and production of the discovery?
With a discovery of this potential significance, there are often political voices that would like
to start spending money and accelerate timelines or cut corners to meet political rather than business cycles. I would encourage the country to stay on a disciplined path: to focus on the technical elements, safety and environmental performance, among others. The world, investors and the broader industries are watching how Namibia manages this discovery. It will be important that the country and the private sector execute the plan.
What should be done from a regulatory point of view to develop an oil and gas bill?

Namibia’s lack of discovery success in the past has meant
it could watch the rest of the world test different models. I would encourage the country to integrate the best elements and reject the bits that compromise the country’s values. We know that Namibia wants to increase foreign investment. Identify and integrate those factors into legislation. The country would also like to ensure a longterm industry. The regulatory context and fiscal regime should incentivise those goals rather than short-term returns. Further, since resource projects —oil, gas, mining—are longterm investments, all market participants should expect certainty in decision-making.
54 African mining news Issue 6 OIL
The world, investors and the broader industries are watching how Namibia manages this discovery.













































Premium quality Aluzinc steel sectional tanks for bulk water storage throughout Africa • High corrosion resistance • Cost effective • On-site assembly • Tough and durable • Low maintenance • 5kL to 4000kL • Steel-domed roofs or open-top tanks • Human consumption/ food grade certified • Tanks < 350kL require no concrete foundation Proud BBBEE Level 2 Contributor sales@rainbowres.com | +27 (0)11 965 6016 | +27 (0)83 226 8572 www.rainbowtanks.co.za MINING | INDUSTRY | MUNICIPAL | AGRICULTURE | FOOD AND BEVERAGE | FIRE FIGHTING accredited
What will the discovery mean for local content?
It is appropriate to encourage local content, especially where that content can add real value to the enterprise. In practice, the best application of local content is when there is clear alignment between the local business or workforce and the project. At the discovery stage, there is likely little opportunity for local content, since there is still more of a design phase. However, I would expect there would be more opportunity for local content as the onshore services will be required when the project advances. I would think there may be some initial training opportunities for local businesses and education to explore what those future win-win situations may be in the near- to mid term.
How does this discovery work in the face of energy transition, and what is the environmental impact?
High oil and gas prices have underscored that we will need oil and natural gas for many years into the future. The transition away from oil will take many decades, and it will be uneven with certain regions able to transition sooner than others.

Yet, increasing calls to address climate change and transition away from hydrocarbons are very real. The market, investors, shareholders and the public, more broadly, will increasingly demand that those hydrocarbons be produced safely and environmentally sustainable. I suspect that concepts align with most Namibians, particularly given the importance of tourism.
It will be important for Namibia or any other project in the world to demonstrate it is operating with the environment in mind and with the highest standards.
African Energy Chamber (www.EnergyChamber.org)
56 African mining news Issue 6 OIL
WEALTH FOR ALL
Ground-breaking five-year wage agreement between Siyanda Bakgatla Platinum Mine, AMCU and NUM
In February 2022, Siyanda Bakgatla Platinum Mine negotiated a historic wage agreement with the Association of Mineworkers and Construction Union (AMCU) and the National Union of Mineworkers (NUM) for the period 1 March 2022 to 28 February 2027.

Says SBPM executive for Sustainable Development and HR, Hope Tyira, “Thanks to our strong and mature relationships with our workers and their representatives, we have a longterm contract that will benefit all our employees. Having certainty with regard to our wage bill for the next five years allows us to plan and secure the sustainability of our mine as we create wealth for all our stakeholders.”
He adds, “I believe both unions signing such an agreement is a first in the mining industry in South Africa.”
SBPM enjoys sound employee relations, based in part on the share participation scheme that ensures employees own 7.3% of the mine, while the host communities own 27% through a trust.

Tyira notes it is important for these two key stakeholders to participate in the value added by SBPM. “They are part owners and are committed to ensuring the long-term sustainability of SBPM. This year, SBPM paid dividends amounting to R84 million —and each qualifying employee received an average of R14 000. The dividends are over and above their usual monthly bonuses.”
This new collective agreement, concluded in terms of the Labour
HOPE TYIRA - Executive Head: Sustainable Development and HR

Relations Act, covers specific wage increases for the next five years and a number of allowances: homeowners’ allowances, living out allowances, rock drill operators’ and sewerage plant allowances, medical aid, and provident fund contributions, long service awards, as well as family responsibility/parental leave. The agreement precludes industrial action on matters covered in the contract.
Tyira says, “We are delighted that the unions have agreed to support us in our application to the Department of Labour for exemptions of the Basic Conditions of Employment Act for the five-year period due to operational requirements relating to shift schedules. They will also support management in our efforts to reduce absenteeism. We have a great relationship with the unions, and the beautiful thing here is that the unions are actually the owners of this mine, having 7.3% ownership of this mine.”
He explains, “How we’ve structured the deal is that the C1 to D1 employees basically get 5.5% for year 1 to year 3. We’ve paid a premium for year 4 and year 5 by giving them 7% guaranteed. This is over and above the allowances. With A to B7 categories, we’ve ensured we’ve given them a higher percentage with 6.5% in the first three years with the premium in the last years, to basically make it worth their while to consider this long-term deal.”
Jimmy Gama, AMCU national treasurer, concurred that “this is a very good agreement. We really appreciate
the engagement that we’ve had with the company and the positivity on the side of the company. We always find it difficult to engage with other companies when it comes to wage negotiations, but we appreciate SBPM senior management and it encourages us to see a wholly owned black company positive on this type of issue rather than taking a negative view.
“We believe this is a living agreement in terms of our members in general. If you take a year 1 increase, it takes that employee to a figure of R16 352—which is a living wage that AMCU has always been fighting for. And we believe that in year 5, there will be no employee from Siyanda earning less than R21 000 basic salary.”
NUM deputy general-secretary William Mabapa is more cautious, saying the union needs “time to unpack this five-year agreement”. He explains that, “The package that is inside that agreement is so attractive that you will want to secure it for a period of time. Because you are not sure what the employer may say— anything can happen. Any agreement can be renegotiated if parties realise that we are part of this agreement, but there are challenges that are compelling us to do [unpacking].”
Tyira reiterates that stability is the major issue—for the employees and for the communities served by SBPM. “I hope the industry can learn from this in terms of getting stability, and that the unions can take it forward to make sure our industry is stable.”
Issue 6 African mining news 57 ADVERTORIAL
CLEAN, AFFORDABLE POWER
Equatorial Guinea models success of US investment in African gas

58 African mining news Issue 6 GAS
United States operators, including Noble Energy, Marathon Oil and Chevron, have played a critical role in executing the first phase of Equatorial Guinea’s flagship Gas Mega Hub—serving as a model for future US investment in gas value chains across the continent.

The African natural gas value chain has become the preferred destination for foreign direct investment: not only because the continent holds over 500 trillion cubic feet of proven reserves but also because natural gas is a critical step in the global energy transition and provision of clean, affordable power. In the US, the Biden Administration has made clear its commitment to supporting developing countries in their own pursuit of low- or zero-carbon economies.
Home to 1.3 trillion cubic feet of natural gas, Equatorial Guinea exemplifies the impact of US private investment on its domestic gas monetisation drive to date, as well as the myriad opportunities still available to US investors and suppliers within Africa’s fast-growing gas market.
Since the entry of ExxonMobil in 1994 and its subsequent discovery of the prolific Zafiro field, US operators have played a major role in Equatorial Guinea’s hydrocarbons development. In fact, the US represents the single largest foreign investor in Equatorial Guinea, which the country acknowledges through exclusive privileges like visa-free travel for Americans. Since then, oil and gas independents like Marathon Oil and Kosmos Energy have entered the upstream space, along with supermajor Chevron
via its acquisition of Noble Energy in October 2020. In partnership with the Ministry of Mines and Hydrocarbons, these companies have directly financed and developed Equatorial Guinea’s flagship Gas Mega Hub project, which targets the creation of an intra-African liquefied natural gas (LNG) trade through the development of several offshore gas hubs and monetisation of neighbouring gas reserves.
The first phase of the Gas Mega Hub was the successful completion of the $330-million Alen gas monetisation project, which supplies gas from the Noble Energy–operated Alen Field to onshore gas-processing facilities at Punta Europa on Bioko Island. In April 2019, Noble Energy signed definitive agreements with Marathon Oil and the Government of Equatorial Guinea for tolling
Issue 6 African mining news 59 GAS
The African natural gas value chain has become the preferred destination for foreign direct investment
Alen Unit gas through the Alba liquefied petroleum gas plant and EG LNG production facility, in which Marathon Oil is a majority shareholder. In February, Chevron, as the new operator of the Alen Unit, achieved first gas flow from the project, with new companies set to lift LNG cargoes directly from the EG LNG plant this year.
On top of revenues generated from the sale of gas on the global market, the African natural gas value chain offers a series of integrated foreign investment and export opportunities, including the creation of onshore manufacturing jobs in the US. In addition to minor modifications made to the Alen offshore platform to export gas—as well as modifications to the Alba plant to receive gas—Alen Unit partners installed and currently operate a 70-kilometre pipeline to transport gas from the Alen
Unit to Punta Europa. Bilateral co-operation within trade and investment between the two countries enables the provision of US exports required for the development and construction of pipelines, platforms and associated infrastructure.
Another link within the African gas value chain that has been pioneered by Equatorial Guinea and capitalised on by US suppliers is small-scale LNG, in which excess gas capacity is redirected to find new customers and supply smaller scale power plants and projects. Because small-scale LNG caters to power generation for off-grid or remote users, it can foster demand in areas that were not previously reached by traditional LNG.
In Equatorial Guinea, the country’s Gas Mega Hub paved the way for the construction of West Africa’s first LNG storage
and regasification plant. Built by American manufacturer Corban Energy Group and located at the Port of Akonikien, the plant will enable the transportation and storage of LNG from the Punta Europa LNG Terminal to Akonikien on the southern border of the mainland. It will then be fed into the regasification plant to be distributed to smaller scale power plants and LNG power stations throughout the country.
According to Mordor Intelligence reports, the global small-scale LNG market features a compound annual growth rate of 21.34% between 2020 and 2025, in which US investors can play a critical role in supplying investments in capital and technology.
 Grace Goodrich Field Editor Energy Capital & Power
Grace Goodrich Field Editor Energy Capital & Power
Equatorial Guinea exemplifies the impact of US private investment on its domestic gas monetisation drive to date.
60 African mining news Issue 6 GAS















DOWN BELOW
More than 100 countries, including the United States and members of the European Union, have committed to net-zero carbon emissions by 2050. The world is going to need a lot of metal, particularly copper.
Recently, the International Energy Agency sounded the warning bell (bit.ly/3aRbYXE) on the global supply of copper as the most widely used metal in renewable energy technologies. With Goldman Sachs predicting (bit.ly/3AWIPES) copper demand to grow up to 600% by 2030 and global supply becoming increasingly strained, it is clear we need to find new and
large deposits of copper fast.
Getting this much copper will be impossible unless we discover significant new copper deposits. But there has been little exploration for copper over the past decade, as prices have been relatively low.
We have been developing software to model Earth in four dimensions to look deep inside the planet and back into the past (bit.ly/3DVg39C) to discover where copper deposits formed along ancient mountain ranges. This software, called GPlates (www.gplates.org), is a powerful fourdimensional information system for geologists.

62 African mining news Issue 6 MINERALS
Travelling through deep time to find copper for a clean energy future




How large copper deposits form


Many of the world’s richest copper deposits formed along volcanic mountain chains such as the Andes and the Rocky Mountains. In these regions, an oceanic tectonic plate and a continent collide, with the oceanic plate sinking under the edge of the continent in a process called subduction.
This process creates a variety of igneous rocks and copper deposits to form along the edge of the continent, at depths of between one and five kilometres in the crust, where hot magmatic fluids containing copper (and other elements) circulate within networks of faults. After millions of years of further plate movement and erosion, these treasures move close to the surface—ready to be discovered.
Searching for copper
Geologists typically use a set of well-established tools to look for copper. These include geological mapping, geochemical sampling, geophysical surveys and remote sensing. However, this approach does not consider the origin of the magmatic fluids in space and time as the driver of copper formation.


We know these magmatic fluids come from the ‘mantle wedge’, a wedge-shaped piece of the mantle between the two plates that is fed by oceanic fluids escaping from the down-going plate. The oceanic plate heats up on its way down, releasing fluids that rise into the overlying

continental crust, which in turn drives volcanic activity at the surface and the accumulation of metals such as copper.
Differences in how subduction occurs and the characteristics of the oceanic plate may hold the secret to better understanding where and when copper deposits form. However, this information is traditionally not used in copper exploration.
Building a virtual Earth
At the EarthByte (www.earthbyte. org) research group, we are building a virtual Earth powered by our GPlates plate tectonic software, which lets us look deep below the surface and travel back in time. One of its many applications is to understand where copper deposits have formed along mountain belts.
In a recent paper, we outline how it works. We focus on the past

80 million years because most of the known economic copper deposits along mountain belts formed during this period. This period is also most accurate for our models (bit.ly/3pg2m19)
We used machine learning to find links between known copper deposits along mountain belts and the evolution of the associated subduction zone. Our model looks at several different subduction zone parameters and determines how important each one is in terms of association with known ore deposits.
So, what turns out to be important? How fast the plates are moving toward each other, how much calcium carbonate is contained in the subducting crust and in deep-sea sediments, how old and thick the subducting plate is, and how far it is to the nearest edge of a subduction zone.
64 African mining news Issue 6
C M Y CM MY CY CMY K
MINERALS










































Oil & Fuel Analysis | Transformer Chemistry Services | Reliability Solutions Download our brochure +264 81 229 6926 support@wearcheck.co.za wearcheckafrica WearCheck www.wearcheck.co.za Branches Botswana DRC Ghana Mozambique Namibia Uganda Zambia Zimbabwe +267 311 6829 +260 977 622 287 +233 54 431 6512 +258 85 792 7933 +264 81 141 7205 +256 78 529 6994 +260 212 210 161 +263 24 244 6369 WearCheck, Africa's leading condition monitoring company, is dedicated to saving money for you, our customers. We analyse data from condition monitoring and fluid analysis to schedule maintenance and avoid unexpected machine failure. Accurately predicting maintenance = saving you time and money. Condition Monitoring is at the heart of machine reliability Oil & Fuel Analysis | Transformer Chemistry Services | Reliability Solutions Download our brochure +264 81 229 6926 support@wearcheck.co.za wearcheckafrica WearCheck www.wearcheck.co.za Branches Botswana DRC Ghana Mozambique Namibia Uganda Zambia Zimbabwe +267 311 6829 +260 977 622 287 +233 54 431 6512 +258 85 792 7933 +264 81 141 7205 +256 78 529 6994 +260 212 210 161 +263 24 244 6369 WearCheck, Africa's leading condition monitoring company, is dedicated to saving money for you, our customers. We analyse data from condition monitoring and fluid analysis to schedule maintenance and avoid unexpected machine failure. Accurately predicting maintenance = saving you time and money. Condition Monitoring is at the heart of machine reliability C M Y CM MY CY CMY K Oil & Fuel Analysis | Transformer Chemistry Services | Reliability Solutions Download our brochure +264 81 229 6926 support@wearcheck.co.za wearcheckafrica WearCheck www.wearcheck.co.za Branches Botswana DRC Ghana Mozambique Namibia Uganda Zambia Zimbabwe +267 311 6829 +260 977 622 287 +233 54 431 6512 +258 85 792 7933 +264 81 141 7205 +256 78 529 6994 +260 212 210 161 +263 24 244 6369 WearCheck, Africa's leading condition monitoring company, is dedicated to saving money for you, our customers. We analyse data from condition monitoring and fluid analysis to schedule maintenance and avoid unexpected machine failure. Accurately predicting maintenance = saving you time and money. Condition Monitoring is at the heart of machine reliability Oil & Fuel Analysis | Transformer Chemistry Services | Reliability Solutions Download our brochure +264 81 229 6926 support@wearcheck.co.za wearcheckafrica WearCheck www.wearcheck.co.za Branches Botswana DRC Ghana Mozambique Namibia Uganda Zambia Zimbabwe +267 311 6829 +260 977 622 287 +233 54 431 6512 +258 85 792 7933 +264 81 141 7205 +256 78 529 6994 +260 212 210 161 +263 24 244 6369 WearCheck, Africa's leading condition monitoring company, is dedicated to saving money for you, our customers. We analyse data from condition monitoring and fluid analysis to schedule maintenance and avoid unexpected machine failure. Accurately predicting maintenance = saving you time and money. Condition Monitoring is at the heart of machine reliability CMY
OUR APPROACH
OUR APPROACH
WE APPLY PRACTICAL INDUSTRY BEST PRACTICES IN OUR OPERATONS TO MEET INTERNATIONAL STANDARDS IN MINING.
Using our machine learning approach (bit.ly/3aSuIpz), we can look at different parts of the world and see whether they would have experienced conditions conducive to forming copper deposits at different times. We identified several candidate regions in the US, including in central Alaska, southern Nevada, southern California and Arizona, and numerous regions in Mexico, Chile, Peru and Ecuador.
WE APPLY PRACTICAL INDUSTRY BEST PRACTICES IN OUR OPERATONS TO MEET INTERNATIONAL STANDARDS IN MINING.
Knowing when copper ore deposits might have formed is important, as it helps explorers focus their efforts on rocks of particular ages. In addition, it reveals how much time given deposits might have had to move closer to the surface.
and require virtual Earth models to look much further back in time than those applied to the Americas.

The future of mineral exploration
These emerging technologies are increasingly being used by Australian startups like Lithodat (lithodat.com) and DeeperX (www.deeperx.com) and mining companies in collaboration with universities to develop AI’s enormous potential for critical minerals discovery (bit.ly/3BUJS9R).
Australia has similar deposits, including the Cadia coppergold district in New South Wales. However, these rocks are significantly older (roughly 460 million to 430 million years old)
Finding 10 million tonnes of copper by 2030—the equivalent of eight of the largest copper deposits that we mine today —presents an enormous challenge. (bloom.bg/2Z5qgS4). With support over a decade from AuScope (www.auscope. org.au) and the National Collaborative Research Infrastructure Strategy (www.dese.gov.au/ncris), we are in a position to imagine tackling this challenge. By supercharging GPlates in Australia’s Downward Looking Telescope (bit.ly/3n8QHhH), together with AI and supercomputing, we can meet it head on.
Dietmar Müller
Professor: Geophysics
University of Sydney
Jo Condon
Maloma (MCL) is a coal mine operation located in the Shiselweni and Lubombo regions of the Kingdom of Eswatini. The mine commenced its operations in 1992 and produces anthracite coal which is primarily utilized in the steel and metallurgical industries. The history of the company’s shareholding includes Tibiyo Taka Ngwane partnering with several commercial shareholders over the years at 50 joint shareholdings.
Honorary Researcher
The University of Melbourne
Maloma (MCL) is a coal mine operation located in the Shiselweni and Lubombo regions of the Kingdom of Eswatini. The mine commenced its operations in 1992 and produces anthracite coal which is primarily utilized in the steel and metallurgical industries. The history of the company’s shareholding includes Tibiyo Taka Ngwane partnering with several commercial shareholders over the years at 50 joint shareholdings.




Julian Diaz
Exploration Geologist University of Sydney
+268 2207 3000
+268 2207 3000
Excellence Driven By Values
Excellence Driven By Values
66 African mining news Issue 6 MINERALS
OUR APPROACH
OUR APPROACH WE APPLY PRACTICAL INDUSTRY BEST PRACTICES IN OUR OPERATONS TO MEET INTERNATIONAL STANDARDS IN MINING.
IN MINING.
OPERATONS TO MEET INTERNATIONAL STANDARDS IN MINING.
PRACTICAL
OPERATONS TO MEET INTERNATIONAL STANDARDS IN MINING.
OUR APPROACH WE APPLY PRACTICAL INDUSTRY BEST PRACTICES IN OUR OPERATONS TO MEET INTERNATIONAL STANDARDS IN MINING.
APPROACH WE APPLY PRACTICAL INDUSTRY BEST PRACTICES IN OUR OPERATONS TO MEET INTERNATIONAL STANDARDS IN MINING.
WE APPLY PRACTICAL INDUSTRY BEST PRACTICES
OPERATONS TO MEET INTERNATIONAL STANDARDS IN MINING.
OUR APPROACH WE APPLY PRACTICAL INDUSTRY BEST PRACTICES IN OUR OPERATONS TO MEET INTERNATIONAL STANDARDS IN MINING.
Maloma (MCL) is a coal mine operation located in the Shiselweni and Lubombo regions of the Kingdom of Eswatini. The mine commenced its operations in 1992 and produces anthracite coal which is primarily utilized in the steel and metallurgical industries. The history of the company’s shareholding includes Tibiyo Taka Ngwane partnering with several commercial shareholders over the years at 50 joint shareholdings.
Maloma (MCL) is a coal mine operation located in the Shiselweni and Lubombo regions of the Kingdom of Eswatini. The mine commenced its operations in 1992 and produces anthracite coal which is primarily utilized in the steel and metallurgical industries. The history of the company’s shareholding includes Tibiyo Taka Ngwane partnering with several commercial shareholders over the years at 50 joint shareholdings.
Maloma (MCL) is a coal mine operation located in the Shiselweni and Lubombo regions of the Kingdom of Eswatini. The mine commenced its operations in 1992 and produces anthracite coal which is primarily utilized in the steel and metallurgical industries. The history of the company’s shareholding includes Tibiyo Taka Ngwane partnering with several commercial shareholders over the years at 50 joint shareholdings.
Maloma (MCL) is a coal mine operation located in the Shiselweni and Lubombo regions of the Kingdom of Eswatini. The mine commenced its operations in 1992 and produces anthracite coal which is primarily utilized in the steel and metallurgical industries. The history of the company’s shareholding includes Tibiyo Taka Ngwane partnering with several commercial shareholders over the years at 50 joint shareholdings.
Maloma (MCL) is a coal mine operation located in the Shiselweni and Lubombo regions of the Kingdom of Eswatini. The mine commenced its operations in 1992 and produces anthracite coal which is primarily utilized in the steel and metallurgical industries. The history of the company’s shareholding includes Tibiyo Taka Ngwane partnering with several commercial shareholders over the years at 50 joint shareholdings.
























+268 2207 3000
+268 2207 3000
Excellence Driven By Values
Excellence Driven By Values
Excellence Driven By Values
Excellence Driven By Values
Excellence Driven By Values
Excellence Driven By Values
Maloma (MCL) is a coal mine operation located in the Shiselweni and Lubombo regions of the Kingdom of Eswatini. The mine commenced its operations in 1992 and produces anthracite coal which is primarily utilized in the steel and metallurgical industries. The history of the company’s shareholding includes Tibiyo Taka Ngwane partnering with several commercial shareholders over the years at 50 joint shareholdings. Excellence Driven By Values
Maloma (MCL) is a coal mine operation located in the Shiselweni and Lubombo regions of the Kingdom of Eswatini. The mine commenced its operations in 1992 and produces anthracite coal which is primarily utilized in the steel and metallurgical industries. The history of the company’s shareholding includes Tibiyo Taka Ngwane partnering with several commercial shareholders over the years at 50 joint shareholdings.
Excellence Driven By Values
Maloma (MCL) is a coal mine operation located in the Shiselweni and Lubombo regions of the Kingdom of Eswatini. The mine commenced its operations in 1992 and produces anthracite coal which is primarily utilized in the steel and metallurgical industries. The history of the company’s shareholding includes Tibiyo Taka Ngwane partnering with several commercial shareholders over the years at 50 joint shareholdings.
Maloma (MCL) is a coal mine operation located in the Shiselweni and Lubombo regions of the Kingdom of Eswatini. The mine commenced its operations in 1992 and produces anthracite coal which is primarily utilized in the steel and metallurgical industries. The history of the company’s shareholding includes Tibiyo Taka Ngwane partnering with several commercial shareholders over the years at 50 joint shareholdings. Excellence Driven By Values
OUR
APPLY
INDUSTRY BEST PRACTICES
Excellence Driven By Values
Maloma (MCL) is a coal mine operation located in the Shiselweni and Lubombo regions of the Kingdom of Eswatini. The mine commenced its operations in 1992 and produces anthracite coal which is primarily utilized in the steel and metallurgical industries. The history of the company’s shareholding includes Tibiyo Taka Ngwane partnering with several commercial shareholders over the years at 50 joint shareholdings.
WE
IN OUR OPERATONS TO MEET INTERNATIONAL STANDARDS IN MINING.
APPROACH
IN OUR OPERATONS TO MEET INTERNATIONAL
Excellence Driven By Values
Maloma (MCL) is a coal mine operation located in the Shiselweni and Lubombo regions of the Kingdom of Eswatini. The mine commenced its operations in 1992 and produces anthracite coal which is primarily utilized in the steel and metallurgical industries. The history of the company’s shareholding includes Tibiyo Taka Ngwane partnering with several commercial shareholders over the years at 50 joint shareholdings.
OUR
STANDARDS IN MINING.
OUR APPROACH WE APPLY PRACTICAL INDUSTRY BEST PRACTICES IN OUR OPERATONS TO MEET
STANDARDS
+268 2207 3000 Excellence Driven By Values
Maloma (MCL) is a coal mine operation located in the Shiselweni and Lubombo regions of the Kingdom of Eswatini. The mine commenced its operations in 1992 and produces anthracite coal which is primarily utilized in the steel and metallurgical industries. The history of the company’s shareholding includes Tibiyo Taka Ngwane partnering with several commercial shareholders over the years at 50 joint shareholdings.
INTERNATIONAL
OUR APPROACH
APPLY PRACTICAL INDUSTRY BEST PRACTICES IN OUR OPERATONS TO MEET
WE
INTERNATIONAL STANDARDS IN MINING.
A REALISTIC OPTION
Myths and truths around South Africa’s recent renewable energy auction
At the end of October last year, South Africa’s Department of Mineral Resources and Energy announced its choice of companies to build and operate a new ‘batch’ of renewable energy projects (bit.ly/3HR7NcY). This is part of a programme in which the government invites private companies to compete for contracts to produce electricity and sell it to the national utility, Eskom.

RENEWABLES 68 African mining news Issue 6
www.discoverydrilling.co.za




BOTSWANA
Tel: +26 7 396 0053 Fax: +26 7 396 0143
E-mail: kowie@discoverydrilling.co.bw
SOUTH AFRICA
Tel: +27 14 573 3444/666
E-mail: admin@discoverydrilling.co.za
In this most recent auction of contracts, known as “bid window 5”, 25 projects (12 solar and 13 wind) totalling close to 2 600MW of capacity got the go-ahead. These projects are expected to come online in the next two to three years. The contracts last for 20 years.
The power companies’ bids are scored mainly (90%) on the price at which they will sell electricity. The rest of the scoring (10%) is based on socio-economic development criteria.
Bid window 5 marks the end of a long gap in procurement of renewable energy. South Africa started the procurement programme in 2011, and over the next four years awarded 102 renewable energy projects totalling more than 6 300MW. The programme was stopped in 2015 when Eskom’s leadership at the time refused to sign any more of these power purchase agreements (bit.ly/3zGtnOr).
The bid window 5 results announcement signals a renewed commitment. Prices of
awarded projects are extremely competitive: as low as 34.4c/kWh for onshore wind and 37.4c/kWh for solar PV. The average price for projects in the previous bid window was R1.03/kWh in April 2021 terms. The prices are now competitive with Eskom’s average cost of buying coal in the past financial year: 42c/kWh. And, of course, Eskom has the additional cost of running coal plants.
Thus, it is now theoretically cheaper for Eskom to buy renewable energy from independent power producers than to run its more expensive coal power stations.
The problem is that the power system is severely constrained, and needs much more capacity before this is a realistic option. One also needs more flexible resources on the grid to ensure reliability, and this adds to the costs. But I have been involved in research (bit.ly/3GcPXAF) that shows renewable energy procurement programmes like this can secure projects that are
built cost competitively—if well designed and implemented. This is so even in difficult investment contexts in the global south (bit.ly/3r6NFfQ).
My view is that South Africa’s renewable energy procurement programme has the potential to help restore energy security and eventually reduce power prices. This is despite some concerns that have been raised about the latest bid results. I will explain here why these issues are not reasons for concern.
The concerns
Three main concerns have emerged in response to the bid window 5:
• The prices are too low to be realistic;
• A few bidders will dominate the market; and
• Tariffs for renewables cannot be compared with baseload tariffs.

70 African mining news Issue 6 RENEWABLES
South Africa’s renewable energy procurement programme has the potential to help restore energy security and eventually reduce power prices.
Neuroscience practices and teachings applied to SMEs transform their ability to sustain and grow
Statistics provided by the University of the Western Cape (2020) state that Such Africa has one of the highest failure rates of SMMEs in the world, with at least 70% to 80% of them failing within the first five years, and that only 1% of businesses from previously disadvantaged communities progress to employing more than 10 employees. “These stats are shocking, and only proves just how desperately the SME sector needs direction and new learning abilities coupled with agile thinking and problem-solving strategies,” says Shanilla (Shani) Naidoo, founder of Nemesis Accounting, which is not your average financial accounting services provider.
Nemesis Accounting doesn’t simply take the approach of educating SMEs about accounting, tax and compliance, but also wealth and money management. What it does, however, is to embed in business owners a new way of existing, of maximising human potential and human capital, intrinsically enabling agile and creative thinking—all of which ultimately entrenches correct business principles and strategies with new-age learning skills. The ‘how’ is through the application of neuroscience and neurolinguistic programming.
another from Standard Bank’s Top Women as one of SA’s top Gender Empowerment Companies for 2022. Also this year, Nemesis Accounting is a finalist in the Top Company awards taking place in July 2022 and been positioned as Leader of Empowerment and Transformation in SA business, for 2022.
“I, and Nemesis Accounting, are living proof of the transformative effects of neuroscience, so instead of being just another accounting firm, we have been able to transition into the right fit servicing the SME sector. This holistic integration is threefold: business specialist skills; emotional intelligence; and mental agility. We aim to maximise and engage the human potential and teach applications rather than preach or just disseminate knowledge.
manuals and modules that will give us accreditation with the Quality Council for Trades and Occupations (QCTO).”
says Shani, who applied neuroscience principles to both herself and her business, the results of which elevated the company, and Shani, into the public space via prestigious publications, a nomination for the NSBC’s Small Business Entrepreneur of the Year 2010, yet
“Our training company, for example, teaches as a franchisee, ‘Smart Money’—which presents financial learning, money management and financial growth tools. These are not taught at school, nor do we see any focused sustained drive in the country to intrinsically improve and assist the SME sector, which results in business goals hardly ever achieved,” says Naidoo. “This has always been a huge shortcoming in the business sector, with SMEs falling into a bottomless pit when it comes to their need for professional, costeffective services.
“Our next move is to introduce an entrepreneurial academy and we are currently finalising
Shani is the epitome of a newage businesswoman. She serves as a trustee on the BBBEE share incentive trust, VAE Essop Trust. She is also the public officer for five international companies that have projects in South Africa, and a strategic business adviser to the women’s magazine, 21st Century Women
Success, says Shani, is interpreted in many different ways by different people. “For me, the greatest success is the extent of the capacity that my businesses and I bring about for lasting transformation—be that for businesses or their owners. That I was able to achieve my vision and change the lives of many enterprises, and introduce a new way for accounting practices to operate, means I have created, and continue to create, the value of my intentions.”

“Change the mind first, and the rest becomes simpler to achieve,”
Issue 6 African mining news 71 ADVERTORIAL
says founder of Nemesis Accounting, Shani Naidoo
First, let us consider the claim that “these prices are way too low. The projects will never be built at these costs.” (bit.ly/3nb82Yr)
While the announced prices are indeed around half of those of previous rounds, they are not unrealistic. Global renewable energy auctions have regularly delivered prices like these or even lower in the past two or three years. Examples can be found in Kazakhstan (bit.ly/3Fbv8UT), Saudi Arabia (bit.ly/3fd09Nq), Portugal (bit.ly/3zIO9wP), Chile (bit.ly/31IgCq3), Abu Dhabi (bit.ly/3FdDMlA), the US (bit. ly/3Gdwlwe), Brazil (bit.ly/3JWsSUV) and Uzbekistan (bit.ly/33kDzjf). That is, of course, without the additional requirements embedded in South Africa’s procurement programme which push up capital and operating costs—but the point remains that these prices are feasible.
South Africa also has one of the most onerous and expensive bidding programmes in the world. This is to guard against unrealistic bids being made. The country’s rate of successful bids that translate into projects is more than 95%—one of the best in the world (bit.ly/3Fdj6dJ).
In short, there is no reason to believe that new projects will not reach commercial operation because of prices.
Second, there is the concern that “we are seeing projects awarded to fewer and fewer bidders. Soon the market will be dominated by only a handful of international companies.” (bit.ly/3f9yzks)
While it is true that a small number of winning bidders were awarded the lion’s share of projects in this latest auction, it is not true that this has resulted in market domination. The fact is that competition has been fiercer in each consecutive bidding round, and no company has been able to dominate the market from one round to the next.
A degree of market concentration is inevitable in a competitive bidding process such as South Africa’s. This is because the larger, more experienced bidders are able to use economies of scale, financial innovation, stronger negotiation positions with suppliers and contractors, and vertical integration to reduce costs. In turn, they can offer more competitive tariffs. But a number of mediumsized companies have also been successful (bit.ly/3Fdj6dJ).
And lead bidders represent only one part of the project value chain. Over the years, an extensive ecosystem of service providers and suppliers (bit.ly/32YNbRg) has grown (bit.ly/3t9WhFd) around these projects. In addition, lead bidders are not the only shareholders in these companies. South African shareholders, including black economic empowerment partners and community trusts (bit.ly/3HKcN2O), own 49.4%, on average, in these projects. A third claim is: “you can’t compare the tariffs of these intermittent renewables with that of ‘baseload’, like coal or nuclear”. (bit.ly/331A95e)
Let us address a few issues here. Renewable supply is variable, not intermittent. Power system operators have become good at forecasting when the sun will not shine or the wind will not blow. That means the flexible supply to complement renewable energy can be predicted.
Anyway, ‘baseload’ is an outdated concept (bit.ly/3f9k8gc). It comes from highly centralised power systems where the cheapest electricity was produced by massive coal or nuclear plants that could not be switched on or off quickly. Cheap renewables are challenging this paradigm. Future power systems will be dominated by these variable resources (bit.ly/3HNXwOy), backed up by storage and flexible resources such as gas or hydropower.
South Africa’s 2019 Integrated Resource Plan is premised on supplying reliable power. Its least cost scenarios (bit.ly/3f4tfyK) all pick wind, solar PV plus a flexible resource to meet future power demand securely.

Going forward
There are other concerns (bit.ly/33ijUAP) around the country’s renewable energy independent power producers procurement programme auctions. Maximising and broadening local benefits is important for the wider acceptance of this programme, which cumulatively has resulted in R250 billion investment. But concerns should be based on facts.
The latest auction has resulted in great prices for consumers, and the majority of these projects will be built. Although a small number of international companies are prominent, competition is still fierce. There is a place for local partners and smart medium-sized companies.
As these renewable energy auctions are rolled out, coupled with complementary flexible resources, the country can consign power cuts to history.
Wikus Kruger
Researcher: Renewable Energy University of Cape Town
72 African mining news Issue 6 RENEWABLES

Reconnect with the mining industry in-person Get ready to return to Cape Town as the industry unites to fuel transformations and collaborations. The must attend inperson event will bring together visionaries and innovators and connect you with your next business opportunity. Mining Indaba will be back in Cape Town in 2022 Limited sponsorship and exhibition places remain Enquire today www.miningindaba.com Get ahead of the game by registering your place saving you up to £689 each with the Early Bird rate 9-12 May 2022 | Cape Town, South Africa #MiningIndaba2022
WATCH THIS SPACE
Mining the moon’s water will require a massive infrastructure investment—but should we?



74 African mining news Issue 6 TECHNOLOGY



Simulation & Modelling Occupational Hygiene & Analytical Laboratory Industrial Ventilation Mine Cooling & Heating Engineering & Construction Mine Ventilation PLANNING • SIMULATING • DESIGNING • OPTIMISING SPECIFYING • ENGINEERING • COSTING • BUILDING BBE Group is an independent specialist engineering services provider with over 30 years’ experience with a proven track record in challenging mines and environments MINE VENTILATION AND REFRIGERATION SPECIALISTS www.bbe.co.za Breathing life into mines
We live in a world in which momentous decisions are made by people often without forethought. But some things are predictable, including that if you continually consume a finite resource without recycling, it will eventually run out.
Yet, as we set our sights on embarking back to the moon, we will be bringing with us all our bad habits, including our urge for unrestrained consumption.
Since the 1994 discovery of water ice on the moon by the Clementine spacecraft (go.nasa. gov/3qWtZvi), excitement has reigned at the prospect of a return to the moon. This followed two decades of the doldrums after the end of Apollo, a malaise that was symptomatic of an underlying lack of incentive to return.
That water changed everything. The water ice deposits are located at the poles of the moon, hidden in the depths of craters that are forever devoid of sunlight.
Since then, not least due to the International Space Station, we have developed advanced techniques that allow us to recycle water and oxygen with high efficiency. This makes the value of supplying local water for human consumption more tenuous—but if the human population on the Moon grows, so will demand. So, what to do with the water on the moon?

There are two commonly proposed answers: energy storage using fuel cells (bit.ly/3f4fa4p) and fuel and oxidiser for propulsion (go.nasa.gov/335m32X). The first is easily dispensed with: fuel cells recycle their hydrogen and oxygen through electrolysis when they are recharged, with very little leakage.
Energy and fuel
The second—currently the primary raison d’être for mining water on the moon—is more complex but no more compelling. It is worth noting that SpaceX uses a methane/oxygen mix in its rockets (bit.ly/3f4fnod), so they would not require the hydrogen propellant.
So, what is being proposed is to mine a precious and finite resource and burn it, just like we have been doing with petroleum and natural gas on Earth. The technology for mining and using resources in space has a technical name: in-situ resource utilisation (go.nasa.gov/31FUrk6).
And while oxygen is not scarce on the moon—around 40% of the moon’s minerals comprise oxygen (go.nasa.gov/3te3zYQ)—hydrogen most certainly is.

Extracting water from the moon
Hydrogen is highly useful as a reductant (bit.ly/332W6kw) as well as a fuel. The moon is a vast repository of oxygen within its minerals, but it requires hydrogen or other reductant to be freed.
For instance, ilmenite is an oxide of iron and titanium and is a common mineral on the moon. Heating it to around 1 000ºC with hydrogen reduces it to water, iron metal (from which an iron-based technology can be leveraged) and titanium oxide (bit.ly/3JYxJVS). The water may be electrolysed into hydrogen—which is recycled— and oxygen; the latter effectively liberated from the ilmenite. By burning hydrogen extracted from water, we are compromising the prospects for future generations: this is the crux of sustainability.
Images:
www.nasa.gov
Clementine spacecraft
76 African mining news Issue 6 TECHNOLOGY
The distribution of ice, represented in blue, at the moon’s south pole


Making Agility Count www.randair.co.za
But there are other, more pragmatic issues that emerge. How do we access these water ice resources buried near the lunar surface? They are located in terrain that is hostile in every sense of the word, in deep craters hidden from sunlight—no solar power is available—at temperatures of around 40 Kelvin, or -233ºC. At such cryogenic temperatures, we have no experience in conducting extensive mining operations.


Peaks of eternal light (bit. ly/3naM7Aq) are mountain peaks located in the region of the south pole that are exposed to near-constant sunlight. One proposal from NASA’s Jet Propulsion Lab envisages beaming sunlight from giant reflectors located at these peaks into craters (go. nasa.gov/3qaHAQs). These giant mirrors must be transported from Earth, landed onto these peaks and installed and controlled remotely to illuminate the deep craters. Then, robotic mining vehicles can venture into the now-illuminated deep craters to recover the water ice using the reflected solar energy.
Water ice may be sublimed into vapour for recovery by direct thermal or microwave heating— because of its high heat capacity, this will consume a lot of energy, which must be supplied by the mirrors. Alternatively, it may be physically dug out and subsequently melted at barely more modest temperatures.
Using the water
After recovering the water, it needs to be electrolysed into hydrogen and oxygen. To store them, they should be liquefied for minimum storage tank volume.
Although oxygen can be liquefied easily, hydrogen liquefies at 30 Kelvin (-243ºC) at a minimum of 15 bar pressure. This requires extra energy to liquefy hydrogen and maintain it as liquid without boil-off. This cryogenically cooled hydrogen and oxygen (LH2/LOX) must be transported to its location of use while maintaining its low temperature.
So, now we have our propellant stocks for launching stuff from the moon. This will require a launchpad, which may be located at the moon’s equator for maximum flexibility of launching into any orbital inclination, as a polar launch site will be limited to polar launches—to the planned Lunar Gateway only (www.nasa. gov/gateway). A lunar launchpad will require extensive infrastructure development.
In summary, the apparent ease of extracting water ice from the lunar poles belies a complex infrastructure required to achieve it. The costs of infrastructure installation will negate the cost savings rationale for in-situ resource utilisation.
Alternatives to extraction
There are more preferable options. Hydrogen reduction of ilmenite to yield iron metal, rutile and oxygen provides most of the advantages of exploiting water. Oxygen constitutes the lion’s share of the LH2/LOX mixture. It involves no great infrastructure: thermal power may be generated by modest-sized solar concentrators integrated into the processing units. Each unit can be deployed where it is required—there is no need for long traverses between sites of supply and demand.
Hence, we can achieve almost the same function through a different, more readily achievable route to in-situ resource utilisation that is also sustainable by mining abundant ilmenite and other lunar minerals.
Let us not keep repeating the same unsustainable mistakes we have made on Earth—we have a chance to get it right as we spread into the solar system.
Alex Ellery Canada Research Chair Space Robotics and Space Technology Carleton University
78 African mining news Issue 6 TECHNOLOGY

TOXIC ENVIRONMENT
Zambia must treat children suffering from lead poisoning from mines

80 African mining news Issue 6 HEALTH








Contact us on 0861 55 55 67 to discuss your filtration requirements. Our team is looking forward to helping you in your quest of achieving a zero-emission environment. WEBSITE: www.crosible.co.za CONTACT: 0861 55 55 67 • FILTER PRESS CLOTHS • FILTER PRESSES • FILTER PLATES • FILTER BAGS • FILTER CAGES • PYRO-FLO® 0 EMISSIONS FILTRATION SOLUTIONS.
Zambia must immediately provide medical treatment to thousands of children suffering from lead poisoning, and must take swift steps to clean up areas contaminated by residue from what was once the country’s largest lead mine, United Nations experts have said.


“More than 25 years after the Kabwe mine and smelter closed, it is scandalous that some 300 000 people still have to live on toxic soil,” the experts said.
“ Lead attacks the central nervous system, causing numbness, anaemia, convulsions, brain damage and even death.”
Kabwe, the capital of Zambia’s Central Province, was founded on the discovery of lead and zinc deposits during colonial times and was home to lead mining and smelting from 1904 to 1994, when the government closed the mine. Over three million tonnes of tailings (waste from the mining process), about 2.5 million tonnes of slag (waste from the smelter) and other waste remain in the area.
“With every passing day of lead exposure, children’s health is being damaged and their futures are being compromised,” the experts said. “It is critical to provide specialised treatment to all children and adults who require it.”
The World Health Organisation has concluded there is no safe level of lead in human blood.
In Kabwe’s afflicted townships, over 95% of children have levels of 10µg/dL and above, meaning they are at exposed to serious risks and harms. In 2020, about 2 500 Kabwe children, tested under a World Bank project, were found to have levels of 45μg/ dL and higher—meaning they require immediate chelation therapy, the most common treatment for lead poisoning.
Lead attacks the central nervous system, causing numbness, anaemia, convulsions, brain damage and even death. Women can suffer miscarriages and stillbirths.
Soil is the main source of lead exposure in Kabwe
Image: Human Rights Watch 82 African mining news Issue 6 HEALTH
A sign at the old mine site is intended to deter residents of Kabwe from entering, but many come here anyway for small-scale mining


“Young children are especially vulnerable to the toxic effects of lead and can suffer profound and permanent adverse health effects and disabilities, particularly affecting the development of the brain and the nervous system,” the experts said.
“It is also essential that children are not returned to the contaminated environment once they have completed chelation treatment,” they added. This means Zambia must clean up all residential areas completely and permanently.
“The government is still failing to fully address the lead pollution crisis in Kabwe and ensure sustained testing and treatment for Kabwe’s residents.”
The experts emphasised that states and mining companies have respective duties and responsibilities under the UN Guiding Principles on Business and Human Rights (bit.ly/3tshYAP) to protect, respect and remedy businessrelated human rights abuses.
Some progress was made under a World Bank–funded project that started in 2016. However, the project does not address the source of the contamination, Kabwe

mine’s waste dumps, nor does it entail cleaning up the affected townships in a comprehensive manner.
New sources of lead pollution are appearing in the area as the Zambian government issues licences for small-scale mines, now opening alongside unlicensed mines.
The experts said authorities have not tackled health dangers from small-scale mining that picked up after the main mine closed in 1994.
“Lead poisoning in Kabwe adds up to an assault on the right to life with dignity, the right to health and the right to a clean environment,” the experts said, “and we urge Zambia to take responsibility and do more so that the children of the country are ensured health, well-being and a decent future.”
Office of the UN High Commissioner for Human Rights
Schools, playgrounds, homes and backyards all have high lead levels, so residents are being poisoned on a huge scale
Image: Human Rights Watch 84 African mining news Issue 6 HEALTH
The former mine canal
and short-term trends in the PGMs sector, including industry consolidation, price forecasts and macroeconomic influences
• PGMs producers’ perspectives on growth and future supply, diversification, capital allocation and investment, ESG and net zero targets, and much more
• International investors’ current views on the PGMs industry

• Internal Combustion Engine vs FCEVs vs BEVs – which will be the ultimate winner?
• The growth potential of other applications for PGMs, including industrial, jewellery and investment
• The future role of PGMs in a low-carbon economy and South Africa’s potential to become a global green hydrogen hub

Contact us about sponsorship opportunities: sponsorship@resources4africa.com REGISTER NOW! +27 (0) 11 463 7799 // +27 (0) 61 421 9492 registrations@resources4africa.com // www.pgmsindaba.com Resources for Africa is pleased to announce its fifth annual PGMs Industry Day taking place on Wednesday, 6 April as an in person and online event. Key stakeholders including PGMs producers, users and investors will take an open, honest and frank approach to tackling the key issues facing the PGMs sector in the coming years. This year’s speaker line-up includes:
Implats
Platinum
Platinum
Minerals
Resource Capital Funds
price forecasts
which will be the ultimate winner? • The growth potential of other applications for PGMs, including industrial, jewellery and investment • The future role of PGMs in a low-carbon economy and South Africa’s potential to become a global green hydrogen hub The PGMs Industry Day is brought to you by Resources 4 Africa, the organisers of the Joburg Indaba. “By the industry for the industry” FOR PRODUCERS, INVESTORS AND USERS OF PLATINUM GROUP METALS STRATEGIES FOR A LONG-TERM, SUSTAINABLE INDUSTRY PGMs Industry Day | 6 APRIL 2022 Country Club Johannesburg, Auckland Park & online The organisers retain the right to amend the programme, content, timings and speakers. © Resources For Africa Investment Conferences (PTY) Limited The PGMs Industry Day is sponsored by: Lead Sponsor Sponsors Mining Industry Partners Lead Sponsor Contact us about sponsorship opportunities: sponsorship@resources4africa.com REGISTER NOW! +27 (0) 11 463 7799 // +27 (0) 61 421 9492 registrations@resources4africa.com // www.pgmsindaba.com Resources for Africa is pleased to announce its fifth annual PGMs Industry Day taking place on Wednesday, 6 April as an in person and online event. Key stakeholders including PGMs producers, users and investors will take an open, honest and frank approach to tackling the key issues facing the PGMs sector in the coming years. This year’s speaker line-up includes: Nico Muller, CEO, Implats Natascha Viljoen, CEO, Anglo American Platinum Neal Froneman, CEO, Sibanye-Stillwater Steve Phiri, CEO, Royal Bafokeng Platinum Phoevos Pouroulis, CEO, Tharisa Minerals Stephen Forrest,
Oxford
Investment Team Leader, Resource Capital Funds
Janus Henderson And
include:
PGMs
industry consolidation, price forecasts and macroeconomic influences
growth
supply, diversification, capital allocation and investment,
investors’
PGMs industry
Combustion
vs BEVs
which will be the ultimate winner?
The growth potential of other applications for PGMs, including industrial, jewellery and investment
The future role of PGMs in a low-carbon economy and South Africa’s potential to become a global green hydrogen hub The PGMs Industry Day is brought to you by Resources 4 Africa, the organisers of the Joburg Indaba. “By the industry for the industry” FOR PRODUCERS, INVESTORS AND USERS OF PLATINUM GROUP METALS STRATEGIES FOR A LONG-TERM, SUSTAINABLE INDUSTRY PGMs Industry Day | 6 APRIL 2022 Country Club Johannesburg, Auckland Park & online The organisers retain the right to amend the programme, content, timings and speakers. © Resources For Africa Investment Conferences (PTY) Limited The PGMs Industry Day is sponsored by: Lead Sponsor Sponsors Mining Industry Partners Lead Sponsor Contact us about sponsorship opportunities: sponsorship@resources4africa.com REGISTER NOW! +27 (0) 11 463 7799 // +27 (0) 61 421 9492 registrations@resources4africa.com // www.pgmsindaba.com Resources for Africa is pleased to announce its fifth annual PGMs Industry Day taking place on Wednesday, 6 April as an in person and online event. Key stakeholders including PGMs producers, users and investors will take an open, honest and frank approach to tackling the key issues facing the PGMs sector in the coming years. This year’s speaker line-up includes: Nico Muller, CEO, Implats Natascha Viljoen, CEO, Anglo American Platinum Neal Froneman, CEO, Sibanye-Stillwater Steve Phiri, CEO, Royal Bafokeng Platinum Phoevos Pouroulis, CEO, Tharisa Minerals
SFA Oxford
Investment Team Leader, Resource Capital Funds
Janus Henderson
more…. Key topics to be discussed include: • Global long and short-term trends in the PGMs sector, including industry consolidation, price forecasts and macroeconomic influences • PGMs producers’ perspectives on growth and future supply, diversification, capital allocation and investment, ESG and net zero targets, and much more • International investors’ current views on the PGMs industry • Internal Combustion Engine vs FCEVs vs BEVs – which will be the ultimate winner? • The growth potential of other applications for PGMs, including industrial, jewellery and investment • The future role of PGMs in a low-carbon economy and South Africa’s potential to become a global green hydrogen hub The PGMs Industry Day is brought to you by Resources 4 Africa, the organisers of the Joburg Indaba. “By the industry for the industry” FOR PRODUCERS, INVESTORS AND USERS OF PLATINUM GROUP METALS STRATEGIES FOR A LONG-TERM, SUSTAINABLE INDUSTRY PGMs Industry Day | 6 APRIL 2022 Country Club Johannesburg, Auckland Park & online The organisers retain the right to amend the programme, content, timings and speakers. © Resources For Africa Investment Conferences (PTY) Limited The PGMs Industry Day is sponsored by: Lead Sponsor Sponsors Mining Industry Partners Lead Sponsor Contact us about sponsorship opportunities: sponsorship@resources4africa.com REGISTER NOW! +27 (0) 11 463 7799 // +27 (0) 61 421 9492 registrations@resources4africa.com // www.pgmsindaba.com Resources for Africa is pleased to announce its fifth annual PGMs Industry Day taking place on Wednesday, 6 April as an in person and online event. Key stakeholders including PGMs producers, users and investors will take an open, honest and frank approach to tackling the key issues facing the PGMs sector in the coming years. This year’s speaker line-up includes: Nico Muller, CEO, Implats Natascha Viljoen, CEO, Anglo American Platinum Neal Froneman, CEO, Sibanye-Stillwater Steve Phiri, CEO, Royal Bafokeng Platinum Phoevos Pouroulis, CEO, Tharisa Minerals
Oxford
Investment Team Leader, Resource Capital Funds
Henderson And
more…. Key topics to be discussed include: • Global long and short-term trends in the PGMs sector, including industry consolidation, price forecasts and macroeconomic influences • PGMs producers’ perspectives on growth and future supply, diversification, capital allocation and investment, ESG and net zero targets, and much more • International investors’ current views on the PGMs industry • Internal Combustion Engine vs FCEVs vs BEVs – which will be the ultimate winner? • The growth potential of other applications for PGMs, including industrial, jewellery and investment • The future role of PGMs in a low-carbon economy and South Africa’s potential to become a global green hydrogen hub The PGMs Industry Day is brought to you by Resources 4 Africa, the organisers of the Joburg Indaba. “By the industry for the industry” FOR PRODUCERS, INVESTORS AND USERS OF PLATINUM GROUP METALS STRATEGIES FOR A LONG-TERM, SUSTAINABLE INDUSTRY PGMs Industry Day | 6 APRIL 2022 Country Club Johannesburg, Auckland Park & online The organisers retain the right to amend the programme, content, timings and speakers. © Resources For Africa Investment Conferences (PTY) Limited The PGMs Industry Day is sponsored by: Lead Sponsor Sponsors Mining Industry Partners Lead Sponsor Contact us about sponsorship opportunities: sponsorship@resources4africa.com +27 (0) 11 463 7799 // +27 (0) 61 421 9492 registrations@resources4africa.com // www.pgmsindaba.com is pleased to announce its fifth annual PGMs Industry Day taking place on Wednesday, 6 April as an in person and online event. Key stakeholders including PGMs producers, users and investors will take an open, honest and frank approach to tackling the key issues facing the PGMs sector in the coming years. This year’s speaker line-up includes: Nico Muller, CEO, Implats Natascha Viljoen, CEO, Anglo American Platinum Neal Froneman, CEO, Sibanye-Stillwater Stephen Forrest, Brett Beatty, Partner, MD Australia, Investment Team Leader, Resource Capital Funds Tal Lomnitzer, Senior Portfolio Manager, Janus Henderson And many more…. • Global long and short-term trends in the PGMs sector, including industry consolidation, price forecasts and macroeconomic influences • PGMs producers’ perspectives on growth and future supply, diversification, capital allocation and investment, ESG and net zero targets, and much more • International investors’ current views on the PGMs industry • Internal Combustion Engine vs FCEVs vs BEVs – which will be the ultimate winner? • The growth potential of other applications for PGMs, including industrial, jewellery and investment • The future role of PGMs in a low-carbon economy and South Africa’s potential to become a global green hydrogen hub The PGMs Industry Day is brought to you by Resources 4 Africa, the organisers of the Joburg Indaba. “By the industry for the industry” FOR PRODUCERS, INVESTORS AND USERS OF PLATINUM GROUP METALS STRATEGIES FOR A LONG-TERM, SUSTAINABLE INDUSTRY PGMs Industry Day The organisers retain the right to amend the programme, content, timings and speakers. © Resources For Africa Investment Conferences (PTY) Limited The PGMs Industry Day is sponsored by: Lead Sponsor Mining Industry Partners Lead Sponsor Contact us about sponsorship opportunities: sponsorship@resources4africa.com REGISTER NOW! +27 (0) 11 463 7799 // +27 (0) 61 421 9492 registrations@resources4africa.com // www.pgmsindaba.com Resources for Africa is pleased to announce its fifth annual PGMs Industry Day taking place on Wednesday, 6 April as an in person and online event. Key stakeholders including PGMs producers, users and investors will take an open, honest and frank approach to tackling the key issues facing the PGMs sector in the coming years. This year’s speaker line-up includes: Nico Muller, CEO, Implats
Viljoen, CEO, Anglo American Platinum
Froneman, CEO, Sibanye-Stillwater
Phiri, CEO, Royal Bafokeng Platinum
Pouroulis, CEO, Tharisa Minerals
Forrest, Executive Chairman, SFA Oxford Brett Beatty, Partner, MD Australia, Investment Team Leader, Resource Capital Funds Tal Lomnitzer, Senior Portfolio Manager, Janus Henderson And many more…. Key topics to be discussed include: • Global long
Nico Muller, CEO,
Natascha Viljoen, CEO, Anglo American
Neal Froneman, CEO, Sibanye-Stillwater Steve Phiri, CEO, Royal Bafokeng
Phoevos Pouroulis, CEO, Tharisa
Stephen Forrest, Executive Chairman, SFA Oxford Brett Beatty, Partner, MD Australia, Investment Team Leader,
Tal Lomnitzer, Senior Portfolio Manager, Janus Henderson And many more…. Key topics to be discussed include: • Global long and short-term trends in the PGMs sector, including industry consolidation,
and macroeconomic influences • PGMs producers’ perspectives on growth and future supply, diversification, capital allocation and investment, ESG and net zero targets, and much more • International investors’ current views on the PGMs industry • Internal Combustion Engine vs FCEVs vs BEVs –
Executive Chairman, SFA
Brett Beatty, Partner, MD Australia,
Tal Lomnitzer, Senior Portfolio Manager,
many more…. Key topics to be discussed
• Global long and short-term trends in the
sector, including
• PGMs producers’ perspectives on
and future
ESG and net zero targets, and much more • International
current views on the
• Internal
Engine vs FCEVs
–
•
•
Stephen Forrest, Executive Chairman,
Brett Beatty, Partner, MD Australia,
Tal Lomnitzer, Senior Portfolio Manager,
And many
Stephen Forrest, Executive Chairman, SFA
Brett Beatty, Partner, MD Australia,
Tal Lomnitzer, Senior Portfolio Manager, Janus
many
Natascha
Neal
Steve
Phoevos
Stephen
The PGMs Industry Day is brought to you by Resources 4 Africa, the organisers of the
Indaba. “By the industry for the industry” FOR PRODUCERS, INVESTORS AND USERS OF PLATINUM GROUP METALS STRATEGIES FOR A LONG-TERM, SUSTAINABLE INDUSTRY PGMs Industry Day | 6 APRIL 2022 Country Club Johannesburg, Auckland Park & online The organisers retain the right to amend the programme, content, timings and speakers. © Resources For Africa Investment Conferences (PTY) Limited The PGMs Industry Day is sponsored by: Lead Sponsor Sponsors Mining Industry Partners Lead Sponsor
Joburg
FINDING SOLUTIONS
How
engineered bacteria could clean up oil sands pollution and mining waste
Mining is wasteful and unsustainable, and the industry is in desperate need of effective solutions to treat its large bodies of waste.

86 African mining news Issue 6 ENVIRONMENTAL SAFETY






















Rampant industrialisation has caused our planet to warm at an unprecedented rate (bit.ly/3FdiAwb). Glaciers are melting away and sea levels are rising (go.nasa.gov/3tgTLgG). Droughts last longer and are more devastating. Forest fires are more intense (on.natgeo.com/3JYw8iC). Extreme, once-in-a-generation weather events, such as Category 5 hurricanes, seem to be occurring on an annual basis (bit.ly/3r57ODg).
The environment is indeed in grave health and urgent action is desperately needed. But there is genuine optimism that solutions to some of the largest environmental challenges may finally be at hand.
Take the decades-long problem of oil sands tailings ponds. The recovery of this oil consumes nearly threefold its volume in water (bit.ly/3JS7lNc) and leaves behind a slurry of water, solids and organic contaminants as waste. In Canada, for instance, oil sands operations are into their seventh decade, and more than a trillion litres of wastewater now reside in tailings ponds (bit.ly/31JVjEo).
But a rapidly growing collective of engineers, scientists, activists and entrepreneurs are delivering some of the biggest gains in environmental remediation in recent decades by blurring the lines between physical, biological and digital sciences. We call ourselves synthetic biologists.
I have extensively contributed to research, education, commercialisation and regulation of synthetic biology, including as the founder of Metabolik Technologies: an environmental biotechnology venture that commercialised a first-of-its-kind, low-energy, low-cost and sustainable solution to decontaminate oil sands tailings ponds.
A quick guide to synthetic biology

The underlying premise of synthetic biology is as simple as it is elegant: Nature assembles, dismantles and recycles molecules in the cleanest and most efficient manner imaginable. The unique instructions required to achieve these tasks are found in DNA.
Synthetic biologists investigate natural systems in order to understand these remarkable processes and then use labsynthesised DNA to reprogramme them to perform new tasks or existing tasks more efficiently.
Synthetic biology has been used to improve enzymes, cells and populations of cells for diverse applications such as sensing (bit.ly/3FfeGCU), breaking down hydrocarbons and other ‘forever chemicals’ such as per- and polyfluoroalkyl substances (bit. ly/3JV7JL7) in soil and water and sequestering carbon dioxide and methane (bit.ly/338ckJd).
Importantly, many of the protagonists and influencers of synthetic biology are the millennials and zoomers who were raised on a steady diet of Saturday morning cartoons.
88 African mining news Issue 6 ENVIRONMENTAL
SAFETY





















Once fiction, now a real solution
Genetically engineered bacteria that mopped up oil spills were a staple in Captain Planet and the Planeteers, the animated environmental superhero series that launched in 1990. Whereas two decades ago these concepts were confined to the pages of fiction, they are now a reality owing to advances in molecular biology such as CRISPR genome editing and the advent of fully automated genomic foundries —robotic systems that conduct thousands of experiments a day —for accelerated design-buildtest-learn cycles (bit.ly/3r6IVqH).
Crucially, the successes of synthetic biology in the sphere of environmental remediation have not been one-off demonstrations in academic laboratories. They have been proven in the field at sizeable scales and they have taken large bites out of some of the greatest environmental challenges in the world.

Translating innovations to the field
Tailings ponds contain organic compounds such as naphthenic acid fraction compounds and polyaromatic hydrocarbons that are harmful to aquatic life and human health (bit.ly/3neOtOP) and are notoriously difficult to eliminate from water (bit. ly/3f8UQin). They are also teeming with microbial life. These microbes do not merely survive but thrive in the contaminated water. They sense, ingest and metabolise the toxic compounds in the water, albeit
at very slow rates. My team at the University of British Columbia and our colleagues at Allonnia isolated and studied the genomics of these unique creatures and, in collaboration with Ginkgo Bioworks, are now increasing their appetite for and metabolism of the toxic compounds.
After validating the performance of the microorganisms in the field, the UBC–Allonnia team designed some of the largest treatment systems of their kind to achieve the rates and scales needed to remediate the water (bit.ly/3qZOG9u) within the timeline prescribed in Alberta’s Tailings Management Framework (bit.ly/3zKWJeo).
We will test our treatment system at the tailings ponds in early 2022 to fine-tune the microorganisms and the reactors, and assess the risks. Some of these risks include the inefficacy or higher than expected costs of the technology, the potential damage the microbes may cause to the ecosystem, and whether regulators and shareholders are comfortable with deploying engineered micro-organisms in the environment.
This small group of synthetic biologists succeeded thanks to the ingenuity of the approach and new models of collaboration. The team also involved oil sands operators, engineering design firms, contract manufacturing companies and regulatory experts who were able to leverage each partner’s strengths to reduce the time, expense and uncertainty of developing a practical solution.
The fun has only just begun
Synthetic biologists are only getting started and have now set their sights on a number of similarly large problems. One, in particular, has significant implications for our electric future.
Widespread adoption of electric vehicles could reduce carbon emissions from the transportation sector by nearly 50% (on.nrdc. org/3Fh3PIS). Unfortunately, mining the metals used in electric vehicles damages the environment.
The manufacture of a single electric vehicle generates 250 000 kilogrammes of mining waste and 150 000 litres of an extremely toxic liquid called acid rock drainage (bit.ly/3nguU8N), a major threat to the environment owing to its potentially devastating effect on rivers, streams and aquatic habitats (bit.ly/3nb8k19).
Mining is wasteful and unsustainable, and the industry is in desperate need of effective solutions to treat its large bodies of waste. My new startup company ArqMetal is developing microbial solutions to do away with tailings ponds entirely. If we and others like us are successful, we will eliminate waste, deliver decarbonisation, preserve biodiversity, generate employment and achieve equitable social development. Isn’t this what the architects of the Green New Deal had in mind (nyti.ms/3nfl9rj)?
Vikramaditya G. Yadav
Associate Professor Chemical, Biological & Biomedical Engineering
University of British Columbia
90 African mining news Issue 6 ENVIRONMENTAL
SAFETY
MINING TIMBER (Pty) Ltd
MINING TIMBER (Pty) Ltd
MINING TIMBER (Pty) Ltd
MINING TIMBER (Pty) Ltd







OUR SERVICES
OUR SERVICES
OUR SERVICES
We maintain a consistent and reliable supply of mine support elements to the mines. We do this through having control over all the inputs which makes this possible. Our steel products are manufactured by NHR Manufacturing at our factory in Ga-Rankuwa at the highest quality standard. Our timber products are overseen from plantation, harvesting ,sawmill and transport of the end product to the mines.
We maintain a consistent and reliable supply of mine support elements to the mines. We do this through having control over all the inputs which makes this possible. Our steel products are manufactured by NHR Manufacturing at our factory in Ga-Rankuwa at the highest quality standard. Our timber products are overseen from plantation, harvesting ,sawmill and transport of the end product to the mines.
We maintain a consistent and reliable supply of mine support elements to the mines. We do this through having control over all the inputs which makes this possible. Our steel products are manufactured by NHR Manufacturing at our factory in Ga-Rankuwa at the highest quality standard. Our timber products are overseen from plantation, harvesting ,sawmill and transport of the end product to the mines.
We maintain a consistent and reliable supply of mine support elements to the mines. We do this through having control over all the inputs which makes this possible. Our steel products are manufactured by NHR Manufacturing at our factory in Ga-Rankuwa at the highest quality standard. Our timber products are overseen from plantation, harvesting ,sawmill and transport of the end product to the mines.
At the mines we can provide mine yard management including stock control. We supervise the logistics of the mine support products from surface to underground. This ensures that mines never lose blasts due to a shortage of the support materials that we supply
Our after sales service includes support installation training underground and support effectiveness monitoring. A daily report is generated by
At the mines we can provide mine yard management including stock control. We supervise the logistics of the mine support products from surface to underground. This ensures that mines never lose blasts due to a shortage of the support materials that we supply Our after sales service includes support installation training underground and support effectiveness monitoring. A daily report is generated by each instructor which is circulated to the relevant officials for information and comment.
Solid, end-grain, space etc.
- Pre-stress pots (with or without hooks) - Chocks, slabs, trims, squares

















Raymond Botha – Chief Executive Officer -082 045 2095
Raymond Botha – Chief Executive Officer -082 045 2095
Correll Kritzinger – Administration – 083 235 5997
Raymond Botha – Chief Executive Officer -082 045 2095
Correll Kritzinger – Administration – 083 235 5997
Eric Scholtz – Rock Engineering - 083 455 9651
Correll Kritzinger – Administration – 083 235 5997
Eric Scholtz – Rock Engineering - 083 455 9651
Tony Davidson – Sales – 072 785 3669
Eric Scholtz – Rock Engineering - 083 455 9651

Tony Davidson – Sales – 072 785 3669
Tony Davidson – Sales – 072 785 3669

Shaun McConnachie – Sales – 082 553 4228 Kgomotso Mfulwane – Sales - 082 055 8125
Shaun McConnachie – Sales – 082 553 4228
-
-
Ÿ Ÿ -
-
Ÿ OUR PRODUCTS -
-
Ÿ
Research
forms
We
Ÿ Ÿ
Support
To
Quality
Research
-
Ÿ
At the mines we can provide mine yard management including stock control. We supervise the logistics of the mine support products from surface to underground. This ensures that mines never lose blasts due to a shortage of the support materials that we supply Our after sales service includes support installation training underground and support effectiveness monitoring. A daily report is generated by each instructor which is circulated to the relevant officials for information and comment.
Pre-stress pots (with or without hooks)
Chocks, slabs, trims, squares
Cluster plates
Pencil props, engineered props etc.
Pre-stress pump and hose assembly
Dunnage, laggings
STEEL TIMBER
and Development
part of our strategy
are committed to continuously improve mine support products and systems striving to improve safety, costs, and productivity
Mine Yard Management
Installation Training Rock Engineering Services
summarise:
Assurance and Regular Testing of our products at accredited testing facilities
and Development Support Installation Effectiveness Monitoring and Data reporting
Pre-stress Pack plates - Mats: Solid, end-grain, space etc. OUR TEAM
Ÿ
Ÿ
Ÿ
Expansion Friction Bolts
Ÿ Ÿ -
-
Ÿ
-
Ÿ
Ÿ Ÿ
Cluster plates - Pencil props, engineered props etc.
Headboards complete with pre-stress units - Gumplanks, Gate stalls, wedges
OUR PRODUCTS
Pre-stress pump and hose assembly - Dunnage, laggings
STEEL TIMBER Research and Development forms part of our strategy We are committed to continuously improve mine support products and systems striving to improve safety, costs, and productivity
Mine Yard Management Support Installation Training Rock Engineering Services To summarise: Quality Assurance and Regular Testing of our products at accredited testing facilities Research and Development Support Installation Effectiveness Monitoring and Data reporting - Pre-stress Pack plates - Mats:
OUR TEAM Ÿ
Ÿ
Ÿ
Ÿ
each instructor which is circulated to the relevant officials for information and comment. - Pre-stress pots (with or without hooks) - Chocks, slabs, trims, squares Ÿ Ÿ - Cluster plates - Pencil props, engineered props etc. - Headboards complete with pre-stress units - Gumplanks, Gate stalls, wedges Ÿ OUR PRODUCTS - Pre-stress pump and hose assembly - Dunnage, laggings Ÿ STEEL TIMBER Research and Development forms part of our strategy We are committed to continuously improve mine support products and systems striving to improve safety, costs, and productivity Ÿ Ÿ Mine
Management Support Installation Training Rock Engineering Services To
: Quality
and Regular
of our products at accredited testing facilities Research and
Support
Monitoring and Data reporting -
-
-
-
Ÿ
Yard
summarise
Assurance
Testing
Development
Installation Effectiveness
Pre-stress Pack plates
Mats: Solid, end-grain, space etc.
Split sets – mild steel, galvanised or 3CR12
Hardwood sleepers OUR TEAM
Ÿ
Ÿ
Ÿ
Ÿ
Ÿ Ÿ
-
units -
Ÿ OUR PRODUCTS -
pump and hose assembly -
Ÿ STEEL TIMBER Research and Development forms part of our strategy We are committed to continuously improve mine support products and systems striving to improve safety, costs, and productivity Ÿ Ÿ Mine Yard Management Support Installation Training Rock Engineering Services To summarise: Quality Assurance and Regular Testing of our products at accredited testing facilities Research and Development Support Installation Effectiveness Monitoring and Data reporting -
plates -
space etc. OUR
Ÿ
Ÿ
Ÿ
Ÿ
We maintain a consistent and reliable supply of mine support elements to the mines. We do this through having control over all the inputs which makes this possible. Our steel products are manufactured by NHR Manufacturing at our factory in Ga-Rankuwa at the highest quality standard. Our timber products are overseen
plantation, harvesting ,sawmill and transport of the end product to the
Spiral resin Bolt Combi - Plates Back Anchor Split Set Sieza Jack Headboard Expansion Friction Bolts Safety Net
OUR SERVICES At the mines we can provide mine yard management including stock control. We supervise the logistics of the mine support products from surface to underground. This ensures that mines never lose blasts due to a shortage of the support materials that we supply Our after sales service includes support installation training underground and support effectiveness monitoring. A daily report is generated by each instructor which is circulated to the relevant officials for information and comment. - Pre-stress pots (with or without hooks) - Chocks, slabs, trims, squares
- Cluster plates
Pencil props, engineered props etc. - Headboards complete with pre-stress
Gumplanks, Gate stalls, wedges
Pre-stress
Dunnage, laggings
Pre-stress Pack
Mats: Solid, end-grain,
TEAM
Raymond Botha – Chief Executive Officer -082 045 2095
Correll Kritzinger – Administration – 083 235 5997 Shaun McConnachie – Sales – 082 553 4228
Tony Davidson – Sales – 072 785 3669
Eric Scholtz – Rock Engineering - 083 455 9651
from
mines. MINING TIMBER (Pty) Ltd MINING TIMBER (Pty) Ltd
due
training underground and support effectiveness monitoring. A daily report is generated by each instructor which is circulated to the relevant officials for information and comment. - Pre-stress pots (with or without hooks) - Chocks, slabs, trims, squares Ÿ Ÿ - Cluster plates - Pencil props, engineered props etc. - Headboards complete with pre-stress units - Gumplanks, Gate stalls, wedges Ÿ OUR PRODUCTS - Pre-stress pump and hose assembly - Dunnage, laggings Ÿ STEEL TIMBER Research and Development forms part of our strategy We are committed to continuously improve mine support products and systems striving to improve safety, costs, and productivity Ÿ Ÿ Mine Yard Management Support Installation Training Rock Engineering Services To summarise: Quality Assurance and Regular Testing of our products at accredited testing facilities Research and Development Support Installation Effectiveness Monitoring and Data reporting - Pre-stress Pack plates - Mats: Solid, end-grain, space etc. - Temporary support – Seiza Jacks - Charging sticks - Split sets – mild steel, galvanised or 3CR12 - Hardwood sleepers OUR TEAM Ÿ
OUR SERVICES At the mines we can provide mine yard management including stock control. We supervise the logistics of the mine support products from surface to underground. This ensures that mines never lose blasts
to a shortage of the support materials that we supply Our after sales service includes support installation
Ÿ
Ÿ
Ÿ
Ÿ
Ÿ
Pre-Stressed Pack Plate
Raymond Botha – Chief Executive Officer -082 045 2095
Correll Kritzinger – Administration – 083 235 5997
Shaun McConnachie – Sales – 082 553 4228
Kgomotso Mfulwane – Sales - 082 055 8125
Tony Davidson – Sales – 072 785 3669
Eric Scholtz – Rock Engineering - 083 455 9651

SKILLS DEVELOPMENT 92 African mining news Issue 6
HEAVY LIFTING

Issue 6 African mining news 93 SKILLS DEVELOPMENT
Japan, Hitachi Construction Machinery and UNIDO to train construction equipment operators in Zambia
The United Nations Industrial Development Organization (UNIDO), the Government of Japan, the Government of Zambia and Hitachi Construction Machinery company are joining forces to address the growing demand for skilled construction equipment operators in Zambia’s construction and mining industries.
With the shift in the Zambian economy toward more capitaland skill-intensive sectors such as mining, construction, transportation and manufacturing, the demand for technical skills for the operation of heavy equipment operation has increased.


Construction and mining sector employers struggle to find skilled workers who meet modern machinery operational skills requirements.
The situation is compounded by the need to integrate Fourth Industrial Revolution technologies into heavy machinery operations.
Through a public-private development partnership, the four-year project will align industrial skills development to the needs of the industry and the labour market, ultimately fostering productive youth
employment. This will be achieved by jointly establishing a centre of excellence for construction equipment operator workers at the Kitwe Vocational Training Centre (KVTC). Starting from the third year of project implementation, more than 125 skilled operators are expected to graduate from KVTC on an annual basis.
An exchange of notes between Ryuta Mizuuchi, Ambassador Extraordinary and Plenipotentiary of Japan to the Republic of Zambia, and Khaled El Mekwad, UNIDO Representative of the Regional Office in South Africa, confirmed the financial support of the Government of Japan.
SKILLS DEVELOPMENT
94 African mining news Issue 6

The guest of honour, Felix C. Mutati, Minister of Technology and Science, remarked: “Our focus on this programme will be to bridge that skills gap, but focusing on shifting the curriculum, the learning, orienting it to practical skills that address the challenges that we are facing in the mining and construction industries, focusing on lifting up the vulnerable people, the young women, so that they participate in the job market. And my Ministry is going to shift the focus so that locally we train and empower our people through skills so that we minimise the importation of labour. This we can do as a country and we are fairly equipped.”
Ambassador Mizuuchi said, “With this exchange of notes, we are launching a unique project providing the Zambian youth with opportunities of vocational training, with the participation of Hitachi Construction Machinery Zambia and UNIDO. This project will certainly support the new Zambian Government under President [Hakainde] Hichilema in human resources development as he attempts to empower more young Zambians for the purpose of sustainable development.”
Coumba Mar Gadio, resident co-ordinator of the UN in Zambia reflected: “While educational needs globally are immense, the private sector can leverage their resources and core competencies to support governments to enhance skills development and help unlock the necessary investments to ensure quality learning opportunities are accessible. Projects such as this one can help Zambia achieve this.”
Khaled El Mekwad, UNIDO representative, stated: “UNIDO is pleased to facilitate the interests of public and private sector stakeholders to strengthen the quality and relevance of vocational training and support Zambia’s inclusive and sustainable industrial development within the framework of UNIDO’s Programme for Country Partnership, which is fully aligned with the United Nations Sustainable Development Partnership Framework in Zambia and the country’s Seventh National Development Plan.”

Hideki Hattori, company president of Hitachi Construction Machinery Zambia, said: “Hitachi Construction Machinery Zambia is very pleased to be part of
this programme in partnership with UNIDO, together with the Governments of Zambia and Japan. This will enable us to further contribute to the Zambian society as part of our CSR [corporate social responsibility] and skills development agenda and vision. We know that this will not only be a unique achievement but also a platform to continuously engage the co-operating partners in further improvements and opportunities as we continue to operate within Zambia. We hope other companies will emulate our example and consider similar projects in other sectors within Zambia.”
The exchange of notes in Lusaka was followed by the signing of a Joint Declaration between Yuko Yasunaga, head of the ITPO Tokyo of UNIDO, and Kotaro Hirano, president and CEO of Hitachi Construction Machinery, at Hitachi Construction Machinery’s head office in Tokyo—confirming cooperation toward promoting inclusive and sustainable industrial development in developing countries and economies in transition.
United Nations Industrial Development Organization
SKILLS DEVELOPMENT 96 African mining news Issue 6








We supply anywhere in Africa! 01260.2.indd 1 2022/03/16 16:59
We supply anywhere in Africa!


Engineering Solutions for the Global Mining Industry SOUTH AFRICA OFFICE: +27 11 476-7091 Jim Pooley: +27 82 373 0796 / jim@baraconsulting.co.za Clive Brown: +27 82 557 5373 / clive@baraconsulting.co.za www.baraconsulting.co.za UNITED KINGDOM OFFICE Andrew Bamber: +44 744 486 4046 / bamber@baraconsulting.co.uk Pat Willis: +44 781 018 2169 / patw@baraconsulting.co.uk www.baraconsulting.co.uk Mining Geotechnical Ventilation Mechanical Electrical Metallurgical 210 x 275 white background.indd 1 2021/08/19 11:07 AM

NJ Ayuk presents his recently published book to Zimbabwe President Emmerson Mnangagwa
NJ Ayuk presents his recently published book to Zimbabwe President Emmerson Mnangagwa






































































 Leon van der Merwe and Chido Mafongoya Centurion Law Group
Mozal aluminium smelter established by mining giant BHP Billiton
Leon van der Merwe and Chido Mafongoya Centurion Law Group
Mozal aluminium smelter established by mining giant BHP Billiton



























































 Grace Goodrich Field Editor Energy Capital & Power
Grace Goodrich Field Editor Energy Capital & Power








































































































































































